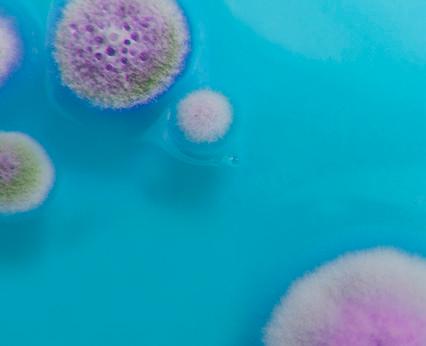

FIRST AID FOR ODOUR

TAKE 100% CONTROL OF YOUR ODOUR REMEDIATION TASKS
![]()
FIRST AID FOR ODOUR

TAKE 100% CONTROL OF YOUR ODOUR REMEDIATION TASKS
CATALOGUE 2026
Vaportek – eliminate odours naturally. Complete product catalog and user manual.



Since 1979

EUROPEAN EXCLUSIVE DISTRIBUTOR FOR DAMAGE RESTORATION
OF SUCCESS IN THE GLOBAL DAMAGE RESTORATION INDUSTRY!
Since 1979, Vaportek has been a leader in pioneering odour remediation products that rely on the power of natural essential oils.









Since the company’s foundation in 1979, Vaportek’s unique technology and products have proven their worth around the world. Today, the products enjoy great recognition for their effectiveness and extremely versatile use for odour remediation within the global damage restoration industry. Today, professionals in the damage restoration industry consider the products to be an indispensable tool for combating odour problems after fire and water damage, etc.
No other odour remediation concept is as versatile and effective to use as Vaportek.
IN THE CASE OF SUDDEN ODOUR NUISANCES, FOR EXAMPLE AFTER A FIRE, IT IS A MATTER OF BEING PROACTIVE, REACTING QUICKLY AND THEREBY CREATING SATISFIED CUSTOMERS.

PROACTIVE HELP YOUR CUSTOMERS IMMEDIATELY
Vaportek’s versatile and effective products can immediately and without risk to the environment and people, reduce the bad smell of smoke and soot that ravages a building after a fire. Do not wait to remove a sudden odour until your customer complains about the smell. Take the initiative yourself, be proactive and remove/ reduce the odour before you get complaints – it makes happy customers. See page 19 for detailed information on first aid, also see the Tips & Tricks section from pages 40-56. Vaportek is not only for first aid, but can of course be used during the entire remediation process.




VAPORTEK – SCIENTIFICALLY FORMULATED TO NEUTRALIZE ODOURS
ESSENTIAL OILS NEUTRALIZE MALODOURS AND AT THE SAME TIME
CONTRIBUTE TO AN AIR-PURIFYING AND ANTISEPTIC EFFECT
The Vaportek method is not an odour masking, but an odour neutralization based on the use of the following two methods: "Zwaardemaker Pairs" and "Van Der Waals’s Forces".
See pages 16-18.
Vaportek neutralizes odours with the power of essential oils, but has the positive side effect that many of the natural oils used smell good. If it smells good - then it’s CLEAN! Most insurance customers appreciate a nice smell after e.g. a fire damage.

The sense of smell is linked directly to the area of the brain called the limbic system which controls memory, emotions and instinctive behaviour. If it smells clean and nice after having completed a damage restoration job, it is perceived by the customer as positive. It provides a positive image of your company and therefore strengthens your competitiveness. Read more on page 17.
Vaportek’s products give you many opportunities to be creative when you have to solve an odour problem. See how you utilize the products’ full potential under the Tips & Tricks section pages 40-56.
For the past 45 years, the damage restoration industry has used the natural and powerful ingredients of Vaportek products to remediate odours after fire damage, water damage, unattended death cleanup, etc. As the European exclusive distributor to the damage restoration industry for more than 20 years, we at NAC Europe know that VAPORTEK GIVES YOUR COMPANY HAPPY CUSTOMERS! The only thing that matters are satisfied and happy customers! Use Vaportek products as your most versatile tool for your various odour remediation tasks and experience top customer satisfaction every time! On the following pages you can learn everything about Vaportek’s technology, products and the many options Vaportek offer.
The Vaportek technology is a unique method of safe, effective and simple odour removal. The method has globally set a standard for ECO- and user-friendly odour remediation within damage restoration.
A scientifically formulated and patented composition of more than 30 different and 100% natural aromatic plant extracts form the foundation of Vaportek’s versatile product range. This complex blend of essential oils is called Neutrox Gamma and was developed in the late 70s by a reputable American pharmaceutical manufacturer for the safe and effective neutralization of malodours within the American healthcare system.
Today, Vaportek is used with great success in many other industries.
The Neutrox Gamma oil is hermetically sealed in a unique plastic membrane. When air is passed over the membrane, using the Vaportek machine’s built-in fan, the oil diffuses through the membrane and is released into the air as a dry vapour.
The essential oil molecules of the dry vapour are extremely active and quickly spread to the entire treatment area to effectively, on a molecular level, encapsulate and neutralize or odour modify odours from fire and soot damage, nicotine, urine, mould, sewage, faeces, stove fire, burned-on food, protein fire, sweat, vomit, food, decay, pets and all other odours of organic origin.
The dry vapour penetrates and effectively treats porous/semiporous, smooth/hard surfaces and materials such as wood, concrete, wallpaper, plaster, bricks, textiles, plastic, etc.
If you have any questions about the products, prices or the discount system, you are very welcome to contact our office at info@nac-europe.com or telephone +45 7442 6292. We speak English, German and Scandinavian.

Jesper Natorp, managing director
Today, Vaportek’s product portfolio consists of several different and completely unique products, which are based on the natural, original and patented Neutrox Gamma oil compound. The products are used with great success in many different industries.

Ozone free.
First aid for odour problems.
The Vaportek method is ECO- and user-friendly. Use Vaportek anywhere, anytime. Use Vaportek before, during and after your damage restoration job.
Vaportek’s active dry vapour treats atmosphere, contents and structure simultaneously. Vaportek – Makes odour treatment simple, fast and effective.





THE FOLLOWING PAGES GIVE YOU A BRIEF OVERVIEW OF TECHNOLOGY, APPLICATION AND PRODUCTS
• Founded in 1979.
• Originally developed for use within the healthcare system.
• Family owned and operated.
•
•

Wisconsin, USA.
WITH ACTIVE DRY VAPOUR
Since 1979

• Essential oils are concentrated, aromatic plant extracts extracted from flowers, bark, leaves, fruits and roots by: 1. Cold pressing, 2. Enfleurage i.e. extraction of essential oils through fats or by 3. Steam distillation.
• Patented blend of essential oils sealed in breathable membranes that release unique odour neutralizing active dry vapour.
• The ECO- and user-friendly alternative to ozone machines, thermofoggers, ULV (ultra low volume) cold foggers or environmentally harmful chemicals.
• Not just a "masking" of the odour, but a true elimination according to the Zwaardemaker Pairs method (Dutch scientist Henrik Zwaardemaker) and Van der Waals’ Forces. See pages 16-18.
• Neutrox Gamma Oil – The Original! Unique and complex blend of essential oils that can be used for all types of odours. Scientifically formulated. See page 36.
• SOS (Smoke Odour Solution) – Unique, complex and brilliant blend of selected essential oils. Specially formulated for all types of smoke and soot odours after wood, paper, synthetic and protein fires. Scientifically formulated. See page 37.
• Lemon and Summer Orange for lighter odour elimination and room freshening. Fresh & Clean Citrus Concept. See page 38-39.




• Used for odour removal in the event of fire/water damage and other damage restoration tasks where odour must be removed or controlled.
• Safe for use within the healthcare system and private homes.
• Examples of applications:
- Food odours (curry, fish, burned-on food, protein fires, etc.).
- Cigarette and other tobacco smoke.
- Fire and soot damage.
- Fuel oil leak.
- Smell of pests.
- Unattended death cleanup.
- Water damage incl. mould and sewage damage.
- Locker rooms and equipment for sports facilities.
- Restaurants/bars with smoke and/or food odours.
- Odours in cars/motorhomes/caravans/boats etc.
- All industrial/production environments with odour problems.
- Animal shelters and clinics ... and much more!
To achieve the best result, it is important to remove the source of the odour, so that odour removal is promoted and the odour is gone for good.




• Dry vapour release is affected by humidity, air flow and temperature. Ideal production of active dry vapour occurs between 10°C and 27°C. Dry vapour release increases significantly at temperatures above 32°C.
• Low room temperatures below 10°C can reduce the generation of active dry vapour from cartridges and membranes.
• Air circulation helps distribute the dry vapour over larger areas.
Use e.g. an air mover to distribute the dry vapour from the Vaporshark faster in the area to be treated.






Ideal for quick control of odours in the event of major and complex losses eg. fire in office buildings, shopping malls, factory halls, etc.
• Vaportek’s unique oil compounds is based on 100% natural essential oils/plant extracts.
• NO OZONE! – NO FOGGING!
• No need for respiratory protection, special permits or extensive training.
• No evacuation/rehousing of residents/injured party.
• No danger to residents upon reoccupation – no quarantine necessary.
• NOTE! Due to the content of natural ingredients, Vaportek’s products can trigger an allergic reaction in sensitive people, but this rarely happens. Contact NAC Europe if this may be a problem. We also have other environmentally friendly solutions for odour removal without plant extracts.




• Leaves NO sticky/greasy surface when the dry vapour is released into the air and treated area.
• Adds NO moisture to the treated areas.
• Requires NO evacuation of the treated area.
• Requires NO disconnection of smoke alarms or electricity.
• Requires NO use of respiratory protection.
• Requires NO special training or license.
• Poses NO ignition/explosion hazard (e.g. when using gas burners/smoking).
• Requires NO removal of plants, electronic equipment, etc.
DRY VAPOUR FROM VAPORTEK ACTIVE DRY VAPOUR FROM VAPORTEK
• Safe to use in residential areas.
• Does not require evacuation of residents or removal of pets, plants, etc.
• Safe to stay in the treatment areas during and after treatment.
• Does not cause oxidation or bleaching of materials and surfaces.
• Does not damage natural rubber (latex), textiles, leather, adhesives, PVC or other materials.
• Can be used in damp environments.
• Forms no harmful by-products.
• Faster treatment/effect.
• Restorator and VaporShark give you many years of effortless operation with low power consumption and no replacement of UV bulbs.
VAPORTEK =

VAPORTEK = SAFE
• Treats rooms up to 2,500 m3 and larger, depending on odour type and intensity.
• Use 1-3 membranes.
• Membranes are available as Neutrox Gamma, SOS (Smoke Odour Solution), Summer Orange and Lemon.
• The lifetime of the membrane is approx. 200-300 hours.
• Solid, lightweight aluminum cabinet.
• Dimensions: 40.5 x 20.5 x 43 cm. Weight: 5.9 kg.
• 220V – built-in fan 1.5 m3/min.
• Popular in the damage restoration industry. Quick first aid for sudden odour problems. See page 19.
Read more about VaporShark on pages 20-21 & 54-56.
• Easy to use, compact electrical machine.
• Treats rooms up to 600 m3, depending on odour type and intensity.
• Uses replaceable cartridges.
• Cartridges are available in Neutrox Gamma, SOS, Lemon, Summer Orange and other aromas.
• The lifetime of the cartridge is approx. 200-300 hours.
• The small but powerful fan distributes the dry vapour quickly and quietly.
• Ideal for damage restoration, hotel rooms, vehicles and many other applications.
• Dimensions: 16 x 13 x 30 cm. Weight: 1.7 kg.
Read more about Restorator on pages 22-23 & 52-53.

READ MORE ABOUT THE VAPORSHARK ON PAGES 20-21
FOR POPULAR USES
PAGES 54-56


READ MORE ABOUT THE RESTORATOR ON PAGES 22-23
FOR POPULAR USES
PAGES 52-53







• Neutrox Gamma Bricks release a harmless dry vapour based on oils extracted from aromatic plants.
• The dry vapour contains a complex composition of more than 30 different and 100% natural plant oils.
• The dry vapour spreads quickly in the air to immediately, on a molecular level, encapsulate and neutralize odours originating from smoke and fire damage, water damage, wastewater damage, pets, pests, stove fire, burned-on food, protein fires, chemical spills, decay, mould, moisture, sewage, waste, food, sweat, urine, vomit, animals, etc.
• Can also be successfully used in dehumidification, air purification and ventilation equipment to control odours related to damage restoration.
Read more about Neutrox Gamma Bricks on pages 26-29 & 40-45.
• Aroma Bricks are identical in form, structure and function to Neutrox Gamma Bricks, but are based on 6 exquisite scent variants, that all please the sense of smell. Aroma Bricks releases a scent into the treated rooms, which suppresses the imaginary residual odour that can occur after e.g. a fire etc.
• Aroma Bricks make your customers happy.
• Can be successfully placed in dehumidification, air purification and ventilation equipment to control odours.
• Aroma Bricks can also be used in vacuum cleaners, and are popular when cleaning and removing odours from contents (furniture etc.). Use your imagination!
• Aroma Bricks are available in the aromas: Lemon, Summer Orange, Ocean, Berry, Linen and Cool Green.
Read more about Aroma Bricks on pages 26-29 & 40-45.
READ MORE ABOUT NEUTROX GAMMA BRICKS AND AROMA BRICKS ON PAGES 26-29
&

FOR POPULAR USES
PAGES 40-45 BESTSELLER DAMAGE
NEW
BRICKS ARE NOW AVAILABLE WITH SOS OIL













• Specially developed for odour remediation when cleaning surfaces after fire damage etc. Add to your rinse water.
• For use on floors, walls and other surfaces. Vaportek’s popular ECOZ concentrates are water-soluble micro-emulsions of essential oils. It is scientifically proven that natural essential oils possess the ability to neutralize odours. Vaportek’s ECOZ products are one of the few products on the market that are composed of genuine essential oils.
• Biodegradable, user-friendly, non-corrosive, leaves no residue or greasy surfaces.
• Available in the aromas: Classic Neutral, SOS, Lemon, Summer Orange and Linen.
Read more about ECOZ on pages 30-31 & 46-49.
• Bio-enzymatic, water-soluble concentrate for odour neutralization and decomposition of organic material.
• Special product from Vaportek consisting of a complex mixture of more than 30 different essential oils (100% plant extracts) and a suspension of microorganisms and enzymes.
• Bio-C promotes and accelerates the natural organic decomposition process by using a powerful blend of special bacterial cultures as well as a stabilized composition of lipase, cellulase, protease and amylase enzymes.
• Eliminates and breaks down odours from faeces, decay, urine, smoke, grease separators, vomit, moisture, mould, sweat, animals, household waste and all other odours of biological/organic origin.
Read more about Bio-C on pages 32-33 & 50-51.

READ MORE ABOUT ECOZ LIQUID ON PAGES 30-31
FOR POPULAR USES

PAGES 46-49

BESTSELLER



READ MORE ABOUT BIO-C ON PAGES 32-33
FOR POPULAR USES
PAGES 50-51
BIO-C REMOVES BIOLOGICAL/ ORGANIC ODOURS






• Contains one membrane – sufficient to treat rooms up to 700 m3 and several 1,000 m3 when placed in ventilation ducts.
• Can be used in front of an air mover or placed in a ventilation system, dehumidification system or similar.
• Available in the following active oils: Neutrox Gamma, SOS, Lemon or Summer Orange.
• Adjustable aluminum disc at the ends enables regulation of dry vapour intensity. Close vent holes by turning the aluminum disc and save cartridge for later use. Can be supplied with cartridge stabilizer.
• Lifetime is approx. 250-300 hours.
• Dimensions: 14.6 x 9.5 cm diameter. Weighs less than 500 g.
Read more about HDS cartridge on pages 34-35.
• Nature Fresh is a cylindrical passive dry vapour system in two sizes.
• Non-electric, just rotate the adjustable top or bottom to control airflow.
• Ideal for areas that require continuous odour control/ deodorization because the source of the malodour is persistent.
• For inhabited areas and applications within the healthcare system, hospitals, industry, vets, fitness centers, etc.
• Damage restoration: can be placed in dehumidification systems when drying out buildings etc.
• Comes with Neutrox Gamma paper membranes, but Neutrox Gamma Bricks and Aroma Bricks can also be used.
Item numbers
56-1302 Small version
56-1303 Large version

READ MORE ABOUT HDS CARTRIDGE ON PAGES 34-35
PAGES 34-35


CONTACT US FOR MORE INFO ABOUT NATURE FRESH

Chain with two clips for hanging Neutrox Gamma Bricks, SOS Bricks, Aroma Bricks or EZ-Disk.


Item number 56-1345 Alligator Clip (Simple Clip System)
boats and caravans. EZ-Twist can be attached to a wall, door, etc. with velcro tape. EZ-Twist releases dry vapour without the use of batteries. The deodorization is adjusted by turning the lid of the EZ-Twist.
EZ-Twist uses EZ-Disk (see page 15). Unique dry vapour – no aerosols or gel.
TIP!
Can also be used with Neutrox Gamma Bricks and Aroma Bricks. The brick is halved in thickness with a hobby knife and the 2 halves are placed on opposite sides of the center pin (see picture).
Item number 21-7601 EZ-Twist Delivered in bags of 12 pieces.

CONTACT US FOR MORE INFO ABOUT VARIOUS AIR MOVERS
PAGES 40-45

CONTACT US FOR MORE INFO ABOUT EZ-TWIST






EZ-Disk, special paper fiber (cellulose) disc saturated with natural aromatic oils.
Used in EZ-Twist and Vaportronic. Neutrox Gamma Bricks and Aroma Bricks can also be used in the Vaportronic.
See picture on the right.
Item number 56-1227 Vaportronic aroma dispenser
Available in the aromas:
56-1323 Neutral/Neutrox Gamma oil. (Bag of 12 pcs.)
56-1939 Ocean (Bag of 12 pcs.)
56-1955 Summer Orange (Bag of 12 pcs.)
56-1322 Lemon (Bag of 12 pcs.)
56-1321 Potpourri (Bag of 12 pcs.)
56-1339 Berry (Bag of 12 pcs.)
56-1338 Orchard (Bag of 12 pcs.)
56-1913 Cool Green (Bag of 12 pcs.)
We recommend Bricks in Vaportronic because of the price savings compared to EZ-Disk.
• Easy to use, compact electrical machine.
• Designed for permanent installation for persistent/ permanent odour nuisances.
• Adjustable output of dry vapour.
• Treats rooms of up to 600 m3, depending on the type and intensity of the odour.
• Uses replaceable Optimum 4000 cartridges: Available in Neutrox Gamma, SOS (Smoke Odour Solution), Lemon, Summer Orange and other aromas.
• Lifetime of the cartridge is approx. 3-5 months.
• Virtually noiseless operation.
• Stable construction with vinyl-coated steel housing with plastic lids at both ends.
• Dim: 13 x 13 x 30 cm. Weight: approx. 2 kg
• For changing rooms, hotel/reception areas, hospitals, hospices/nursing homes, animal hospitals, kennels, prisons, office environments, gyms, etc.
Item number 56-1216 Optimum 4000
CONTACT US FOR MORE INFO ABOUT EZ-DISK & VAPORTRONIC




READ MORE ABOUT OPTIMUM 4000 ON PAGES 24-25



VAN DER WAAL´S FORCE:
This refers to the interactive energy acting between elements of exceedingly small volume. These are forces, such as collision, repulsion and attraction, which control the behavior of nonelectrically charged particles present in a gas. This explains the bonding action between the essential oils and the malodorous materials when in a vapour state.
ZWAARDEMAKER PAIRS:
ESSENTIAL OIL MOLECULE
(e.g. juniper oil)
ODOUR MOLECULE
( e.g. buturic acid)
Zwaardemaker Pairs is based on a scientific discovery which means that if you mix or combine odorous substances, it will result in no smell. This “odour pairing” has proven to be possible with a limited range of essential oils and malodorous targets. This interaction between odorous substances is a phenomenon discovered near the end of the 1800s by the Dutch scientist Zwaardemaker.
STRENGTHEN YOUR COMPANY’S IMAGE BY GIVING YOUR DAMAGE JOB A DISCREET AND POSITIVE SCENT THAT THE CUSTOMER WILL REMEMBER!
It has been scientifically proven that we humans are to a large extent emotionally controlled by our sense of smell. After the sense of sight, the sense of smell has the greatest influence on humans. Imagine that you can do a little extra for your customer via scent and they will remember you for it.




It has been scientifically proven that we humans are to a large extent emotionally controlled by our sense of smell. After the sense of sight, the sense of smell is the one of all our senses that has the greatest influence on humans.
Vaportek’s special oils and compounds are based on 100% natural and highly effective fragrant essential oils, which for 45 years have created convincing results in odour treatment in the professional damage restoration industry worldwide. It is scientifically proven that only natural essential oils possess the ability to neutralize odours. Vaportek’s technology is not a masking of the malodour, but works according to a scientifically proven method called the "Zwaardemaker Smell System" or "Zwaardemaker Pairs".
Vaportek’s technology is based on studies and research by: Hendrik Zwaardemaker Born 10 May 1857, Haarlem Died 19 September 1930, Utrecht Nationality: Dutch Scientific career: Fields Physiology Institutions University of Utrecht Largest scientific work "Physiologie of Olfaction" published in 1895

An important contribution of Zwaardemaker’s studies is the concept of odour conjugates. Zwaardemaker discovered that certain odours could avoid being perceived by the sense of smell if they were mixed with different essential oils. This combination of essential oils and odours is referred to as "Zwaardemaker Pairs" (or Z-pairs).
Vaportek’s products neutralize odours with the power of the fine essential oils which work according to the Zwaardemaker Pairs method. However, much has happened since 1895, when Hendrik Zwaardemaker presented his first studies. You can probably attribute the founder of Vaportek Mr. Jack Bryson a large part of the credit for being one of the people who has managed to see the possibilities in the essential oils and utilized these oils’ potential to the fullest. On this basis, a company has been created with products that have won great respect worldwide within the damage restoration industry, and many other markets. For the past 44 years, the damage restoration industry has used the natural ingredients of Vaportek products to create fragrant and odour-free rooms after fire damage, sewage damage, unattended death cleanup, etc.
Rooms/facilities that have been treated with Vaportek odour treatment products will not be masked with an overpowering scent – but will present themselves as fresh and fragrant – something that the human sense of smell will perceive as very positive. Therefore, Vaportek customers perceive our fragrances as very positive. It brings joy to the customer to return to his newly restored house, where he is met by a fresh hint of eg. citrus scent… THIS IS VAPORTEK!
Insurance customers who have had fire damage or similar, where the damage restoration company has used Vaportek odour removal products, contact us to purchase and use Vaportek products in their daily life to treat odours from pets, cigarette smell, food odours or whatever is relevant for the person concerned.
Butyric acid Vomiting, decay, rancid dairy products
In other situations, it may be desirable to create completely fragrance-free rooms. NAC Europe also has a solution for that. We have a whole programme of other high-tech products that work through oxidation. These can be used separately or in combination with Vaportek.
This is what we call THE BEST OF TWO WORLDS These concepts are presented in NAC’s new "Odour Management Concept". See more on page 59.

People often ask whether Vaportek’s technology masks or truly eliminates malodours. The answer: Vaportek eliminates organic odours.
To mask is to increase overall odour intensity in order to forcibly “cover-up” an existing malodour. This means introducing a new odour that is more powerful smelling than the problematic odour you wanted to eliminate. It results in a further bombardment of perceived scents that does nothing to eliminate the source of the original malodour.
To neutralize is to eliminate or cause malodorous molecules to be imperceptible on a molecular level through direct counteractant measures with an additional compound, in this case, our essential oil compound comprised of plant, flower, and tree extracts. Malodour molecules are then changed through chemical interaction, called odour-pairing or encapsulation, into a new molecular form that either no longer smells or that is not volatile enough to be perceived. In this way, the malodorous molecule is lessened to the point of nonexistence as it has been broken down beyond recognition.
When Vaportek’s essential oil compounds are released into the air as a dry vapour, they react directly with odorous molecules in the air. This molecular, chemical interaction allows Vaportek’s products to effectively neutralize organic malodours.
While Vaportek does introduce an additional fragrance (which some incorrectly attribute to masking) due to our complex formula of naturally occurring essential oils, it is the exact complexity of our oil formula that goes one step further to effectively eliminate the source of the malodorous molecules through encapsulation or odour-pairing neutralization technology. While there are many essential oils, not all of them are capable of neutralizing organic odours such as smoke, urine, skunk, and mildew. Vaportek has carefully crafted the correct blend of oils required for effective and permanent odour elimination. This is why Vaportek’s technology is so unique. Our formula of essential oils offer a broad spectrum neutralization of odour causing elements like aldehyde, amine, diamine, sulfide, lactone, carboxylic acid, ester, carbylamines, ketone, and other carbons.
It is thanks to our essential oils that Vaportek may proudly claim to offer our customers a green solution for their malodour issues rather than be forced to seek out harsh chemicals and ozone producing products. Many existing odour eliminating solutions expose both occupants and the professionals using the equipment to health issues like respiratory disease and lung damage. These products can cause harm to our natural environment too. Our technology is CFC-free, nontoxic, and VOC compliant.

Vaportek further distinguishes itself from competitors with our dry vapour delivery technique which adds zero moisture to the treatment area and is otherwise imperceptible beyond the aroma of essential oils. Our technology doesn’t produce any harmful ozone or hydroxyl, doesn’t involve any fogging equipment, and isn’t as messy or sticky as gels and sprays. Dry vapour compounds have high mobility in the air and are able to safely penetrate porous substances such as wallboard, wood, carpeting, cement, insulation, and other surfaces in a way that competitors’ products cannot.
Vaportek is the pioneering force behind essential oil, dry vapour technology. Vaportek is years ahead of imitation products crafted by companies who are still struggling to achieve the ideal balance of what we discovered and perfected in 1979. Place your trust in Vaportek and our original blend of oils for effective and permanent odour elimination. Beyond our 100% guarantee, we promise impeccable customer service, fair pricing, and a commitment to offer you an environmentally friendly solution for your organic odour problems. We believe in our products and are proud of what we produce. Try us first – we’re all you’ll need!
Here are a few examples of some organic odours our products have been known to effectively neutralize: Mould/mildew, mustiness, pet, urine, smoke/fire, flood, garbage/ dumpster, sweat/athletic, sewage, sour/spoiled dairy, skunk, hydroponic/grow rooms, protein fires, cooking odours like curry, decomposing body, and more!




THERE ARE MANY GOOD REASONS TO USE VAPORTEK PRODUCTS – HERE IS ONE OF THEM!
IN THE CASE OF SUDDEN ODOUR NUISANCES, IT IS ABOUT BEING PROACTIVE, REACTING QUICKLY AND THEREBY CREATING SATISFIED CUSTOMERS
In addition to the fact that Vaportek’s unique technology and products over the past 45 years have proven their worth and effectiveness within the global damage restoration industry, and today are popular products for complete and permanent odour removal throughout the entire remediation process, Vaportek products stand out especially through their versatility and extremely fast effect – especially in case of sudden odour problems.

Here, the Vaportek products provide very quick and superior first aid for odours, which means that likely complaints about smoke and soot smell after a fire in private homes, apartment complexes, companies, stairwells, shopping malls, production halls, etc. can be completely prevented if one or more of the fast-acting Vaportek products are used immediately after the fire, such as a VaporShark, a Restorator or the popular Neutrox Gamma, SOS or Aroma Bricks.

Result = Satisfied customers who feel that you instantly solve their odour problem. Your proactive and quick efforts will be remembered. It strengthens your company’s image!
See how to practice first aid with Vaportek products under the Tips & Tricks section on pages 40-56.
Recommended treatment of sudden or persistent odours related to damage restoration. Extremely safe and effective. A
• No Ozone.
• Popular with cleaning and restoration companies worldwide.
• Immediate results without harmful side effects.
• Fast odour removal promotes customer satisfaction.
• Odour removal is permanent for difficult odours.
• Recommended by the insurance industry.
A B C D E
SOS (Smoke Odour Solution) or Neutrox Gamma oil can be used to treat all types of smoke odour after synthetic fires, wood and paper fires, protein fires, etc.
Install the equipment at the start of the remediation work to immediately reduce odours for restoration technicians and residents.
Safe for use in residential areas during remediation. Simplifies and speeds up cleaning.

Odours from water damage are effectively removed during the treatment. Ideal for use during the drying process. Use e.g. Neutrox Gamma Bricks in dehumidifiers.
Even animal odours can be removed with proper treatment. Also ideal for unattended death cleanup etc.
POWERFUL, EFFICIENT AND VERSATILE ODOUR TREATMENT MACHINE THAT PRODUCES VAPORTEK’S UNIQUE ACTIVE DRY VAPOUR – THE ECO-FRIENDLY ALTERNATIVE TO OZONE TREATMENT
Absolutely unique and highly effective machine for permanent removal of malodours. Leaves the treated rooms with a clean, fresh and natural scent. An excellent and environmentally friendly alternative to ozone treatment, cold fogging and thermofogging.
VaporShark is a portable electric machine that uses a harmless technology that quickly, effectively and permanently removes bad odours and renews the air in indoor spaces. VaporShark uses Vaportek’s patented membrane system, which contains a complex blend of more than 30 different, and 100% natural, essential oils. This means cold pressed and otherwise extracted essential oils from the plant kingdom, such as eucalyptus, cedar, peppermint, camphor, pine, lavender, citrus fruits, etc.
When air is passed over the membrane, using the VaporShark’s built-in fan, the oil diffuses through the membrane and is released into the air as a dry vapour. The plant oil molecules of the dry vapour are extremely active. They quickly spread to the entire treatment area and effectively penetrate porous surfaces, such as wood, concrete, wallpaper, plaster, bricks, insulation materials, textiles, etc. and settles on non-porous surfaces to quickly and effectively encapsulate and neutralize or modify odours at a molecular level. Odours from fire and soot damage, nicotine, urine, mould, sewage, faeces, protein fires, sweat, vomit, food, decay, pets and all other odours of organic origin.



PAGES 54-56

AREAS OF APPLICATION
Used by damage restoration companies all over the world for odour removal after fire damage (protein fire, wood/paper fire or synthetic fire), water damage, sewage damage, stove fires, burned-on food, chemical spills, unattended death cleanup, decay, etc.
50/60 Hz, 230 V 90 m3/t blower





POWERFUL, EFFICIENT AND VERSATILE ODOUR TREATMENT MACHINE THAT PRODUCES VAPORTEK’S UNIQUE ACTIVE DRY VAPOUR





ECO-FRIENDLY TECHNOLOGY
The technology is based on natural plant extracts and is not harmful to humans, and is therefore a better choice than the use of ozone machines, thermal foggers or ULV (cold) foggers and unlike ozone treatment. The VaporShark does not damage textiles, rubber, adhesives, etc. Moisture is not released into the treated rooms. As the method is harmless to humans, there is no need to evacuate rooms treated with the VaporShark or rehouse residents. You can stay in the treated rooms while the Vaporshark is working.
This very versatile odour treatment machine is intended for larger jobs where quick and effective results are desired. Designed for rooms in sizes up to 2,500 m3 and more depending on the type and intensity of the odour.
VAPORSHARK item no. 56-1229
MEMBRANES ARE AVAILABLE IN:
56-1352 Membrane - Neutrox Gamma
56-1766 Membrane - SOS
56-1758 Membrane - Lemon
56-1757 Membrane - Summer Orange
VAPORSHARK TREATS ATMOSPHERE, CONTENTS AND STRUCTURE SIMULTANEOUSLY
THE VAPORSHARK’S SIMPLE AND ROBUST DESIGN GIVES YOU MANY YEARS OF EFFORTLESS OPERATION WITHOUT MAINTENANCE COSTS AND WITH MINIMAL POWER CONSUMPTION - "JUST PLUG AND PLAY"
ATTENTION!
• This system is a safe and effective alternative to ozone, ULV (cold) fogging and thermal fogging.
• No health risks.
• The use of personal protective equipment, e.g. mask is not necessary.
SELECTED SPECIFICATIONS
• Treats areas up to 2,500 m³ and more.
• Stable aluminum lightweight construction.
• Dimensions: 40.5 x 20.5 x 43 cm.
• Weight: 5 kg.
• Membranes are inserted into the VaporShark and release active odour neutralizing dry vapour.
• Power consumption: 36 watt.
• Lifetime membrane: approx. 200-300 hours.
APPLICATIONS FOR VAPORSHARK
• Damage restoration service.
• Food production.
• Slaughterhouses.
• Organic waste treatment.
• Animal shelters.
• Large greenhouses.
• Wastewater treatment plant and installations.
• Extractors/hoods in food production/ restaurants, etc.
• Large halls and meeting rooms, hotels/ exhibition centres, etc.
• Cleaning companies and many others.






TIP: Use ECOZ liquid - odour elimination - in your cleaning/rinse water when cleaning fire damage.
OZONE- AND AEROSOL-FREE METHOD = MAXIMUM SAFETY FOR USERS
COMPACT, EFFICIENT AND VERSATILE ODOUR TREATMENT MACHINE THAT PRODUCES VAPORTEK’S UNIQUE ACTIVE DRY VAPOUR – THE ECO-FRIENDLY ALTERNATIVE TO OZONE TREATMENT
Instructions for use on the side
Opening for inserting cartridges with active oil
Plastic cord with ABS end caps Extra strong designed handle On/Off button
Output of active odour neutralizing dry vapour
Galvanized steel grid

Internal fan, 220 volts. Capacity up to 1.4 m³/min

TIPS &
FOR POPULAR USES
PAGES 52-53 Power consumption: 11 watt


Durable vinyl clad 2.2 mm steel case
1.8 m power cord, 220 volt
Cartridge with active oil for odour treatment (sold separately)

RESTORATOR TREATS ATMOSPHERE, CONTENTS AND BUILDINGS SIMULTANEOUSLY
ATTENTION!
• This system is a safe and effective alternative to ozone, ULV cold and thermal fogging .
• No health risks.
• The use of personal protective equipment is not necessary.
RESTORATOR item no. 56-1226


CARTRIDGES ARE AVAILABLE IN:
56-1387 Cartridge for Restorator/Optimum 4000 - Neutrox Gamma
56-1769 Cartridge for Restorator/Optimum 4000 - SOS
56-1759 Cartridge for Restorator/Optimum 4000 - Lemon
56-1756 Cartridge for Restorator/Optimum 4000 - Summer Orange
56-1765 Cartridge for Restorator/Optimum 4000 - Neutral w. 10% lemon
56-1369 Cartridge for Restorator/Optimum 4000 - Berry
56-1370 Cartridge for Restorator/Optimum 4000 - Orchard
56-1776 Cartridge for Restorator/Optimum 4000 - Ocean




COMPACT, EFFICIENT AND VERSATILE ODOUR TREATMENT MACHINE THAT PRODUCES VAPORTEK’S UNIQUE ACTIVE DRY VAPOUR – THE ECO-FRIENDLY ALTERNATIVE TO OZONE TREATMENT
The Restorator is a simple portable electrical machine that uses a harmless technology that quickly, effectively and permanently removes malodours and renews the air in indoor spaces. The Restorator uses Vaportek’s patented membrane system, which contains a complex mixture of more than 30 different, and 100% natural, essential oils. This means cold pressed and otherwise extracted essential oils from the plant kingdom, such as eucalyptus, cedar, peppermint, camphor, pine, lavender, citrus fruits, etc.
When air passes over the membrane, using the Restorator’s built-in fan, the oil diffuses through the membrane and is released into the air as a dry vapour. The essential oil molecules of the dry vapour are extremely active. They quickly spread to the entire treatment area and effectively penetrate porous surfaces, such as wood, concrete, wallpaper, plaster, bricks, insulation materials, textiles, etc. and settles on non-porous surfaces to quickly and effectively encapsulate and neutralize or modify odours at a molecular level. Odours from fire and soot damage, nicotine, urine, mould, sewage, faeces, stove fire, burned-on food, sweat, vomit, decay, pets and all other odours of organic origin.
ECO-FRIENDLY TECHNOLOGY
The technology is based on natural plant extracts and is not harmful to humans, and is therefore a better choice than the use of ozone machines, thermal foggers or ULV (cold) foggers and unlike ozone treatment. The Restorator does not damage textiles, rubber, adhesives, etc. Moisture is not released into the treated rooms. As the method is harmless to humans, there is no need to evacuate rooms treated with the Restorator or rehouse residents. You can stay in the treated rooms while the Restorator is working.
This very versatile deodorizing machine is intended for areas where quick results are desired, from small rooms, such as car cabins, hotel rooms, to slightly larger rooms of up to 600 m3 (or approx. 250 m2) depending on the type and intensity of the odour.
RESTORATOR TREATS ATMOSPHERE, CONTENTS AND STRUCTURE SIMULTANEOUSLY
THE RESTORATOR’S SIMPLE AND ROBUST DESIGN GIVES YOU MANY YEARS OF EFFORTLESS OPERATION WITHOUT MAINTENANCE COSTS AND WITH MINIMAL POWER CONSUMPTION - "JUST PLUG AND PLAY"
• Treats areas up to 566 m³ or more depending on odour intensity and type.
• Durable construction with 2.2 mm vinyl clad steel case and ABS end caps
• Dimensions: 16 x 13 x 30 cm.
• Weight: 1.7 kg.
• Cartridges are inserted into the Restorator and emit active odour neutralizing dry vapour.
• Power consumption: 11 watt.
• Lifetime cartridge: approx. 200-300 hours.
• Odour remediation after fire/water damage etc.
• Odour treatment of hotel rooms etc.
• Car rental companies (smoke odor etc. in cars).
• Car dealers/camping dealers.
• Hospitals and nursing homes (health care in general).
• Cleaning companies.
• Sports arenas.
• Estate agents/property service.
• The industry in general.
• And many more.

TIP: Use ECOZ liquid - odour elimination - in your cleaning/rinse water when cleaning fire damage.





EFFECTIVE ODOUR TREATMENT – THE ECO-FRIENDLY ALTERNATIVE TO OZONE AND AEROSOLS ETC. Optimum 4000 for permanent installation for persistent odour problems.
Access to cartridge
Output of active odour neutralizing dry vapour
Adjustable output of scent/ dry vapour intensity. Power button.
indicator light
Instructions for use on the underside of the machine.


Wall brackets with lock for permanent installation can be purchased.

Item no. 56-1216

ATTENTION!
• This system is a safe and effective alternative to ozone and spray/aerosol atomization .
• No health risks.

Optimum 4000 cartridge
Cartridge is available in several aromas. The cartridges last approx. 3-5 months.
OPTIMUM 4000 Item no. 56-1216
CARTRIDGES ARE AVAILABLE IN:


56-1387 Cartridge for Restorator/Optimum 4000 - Neutrox Gamma
56-1769 Cartridge for Restorator/Optimum 4000 - SOS
56-1759 Cartridge for Restorator/Optimum 4000 - Lemon
56-1756 Cartridge for Restorator/Optimum 4000 - Summer Orange
56-1765 Cartridge for Restorator/Optimum 4000 - Neutral w. 10% lemon
56-1369 Cartridge for Restorator/Optimum 4000 - Berry
56-1370 Cartridge for Restorator/Optimum 4000 - Orchard
56-1776 Cartridge for Restorator/Optimum 4000 - Ocean




EFFECTIVE ODOUR TREATMENT – THE ECO-FRIENDLY ALTERNATIVE TO OZONE AND AEROSOLS ETC.
Optimum 4000 for permanent installation for persistent odour problems.
FEATURES AND BENEFITS
The Optimum 4000 is Vaportek’s original dry vapour system, first used in cancer wards and other medical facilities in 1979. Optimum 4000 is primarily intended for places with persistent or permanent odour nuisances. Optimum 4000 releases a harmless dry vapour when the odour-neutralizing essential oil, which is sealed in the inner membrane of the cartridge, diffuses out via the surface of the membrane as the air passes by. Simply remove the cap from the cartridge and insert it from the back of the machine and set the desired dry vapour strength. The dry vapour released from the Optimum 4000 is carried by air currents throughout the area to be treated and will quickly control and eliminate odours caused by nicotine, moisture/ mould, food, sweat, faeces, vomit, food, decay, pets and all other odours of organic origin. The active dry vapour treats atmosphere, contents and structure simultaneously.
PLACEMENT
As the dry vapour is heavier than air, it is recommended to place the Optimum 4000 as high as possible. The machine is placed on a hard surface and should only be placed where it is visible during normal operation. The Optimum 4000’s front and back must not be covered. When used in areas where safety is a priority, the Optimum 4000 can be mounted in a wall bracket with a lock, so that unauthorized operation and theft of the unit is avoided.
- Better than ULV cold foggers – leaves no moisture, practically silent and treats larger areas.
- Better than aerosols – safe formulation and more environmentally friendly active ingredients.
- Better than ozone machines – uses harmless essential oils, does not oxidize materials and does not require evacuation of treatment areas.
The adjustable output on the machine ensures complete control of any odour problem. A thermally protected built-in fan works quietly and uses only 16 W of power. The cartridges last approx. 3-5 months.
• Treats rooms up to 500-600 m3 or more.
• Silent operation.
• Stable construction with vinyl clad steel case with plastic lids at both ends.
• Dimensions: 13 x 13 x 30 cm.
• Weight: approx. 2 kg.
• Thermally protected motor with 1.8 m grounded power cord.
• 5 year warranty.
APPLICATIONS
• Examination room
• Hospitals
• Laboratories
• Cleaning service
• Smoking areas
• Veterinary clinics
• Dental practice
• Lobby areas
• Institutions
• Chapels
• Nursing home
• Locker rooms, sports, industry, etc.
• And many more

TIP: Use ECOZ liquid - odour elimination - in your cleaning/rinse water when cleaning fire damage.





Original Neutrox Gamma Bricks have not without reason become a "must have" product in the damage restoration industry. There are many good reasons for that!
Vaportek’s patented and unique odour treatment system sets the standard for environmental and user-friendly odour remediation within the damage restoration industry worldwide.
A scientifically formulated and patented composition of more than 30 different plant extracts form the foundation of Vaportek’s versatile product range. The oil is called Neutrox Gamma and was originally developed for safe and environmentally friendly neutralization of odours within the US healthcare system.
Neutrox Gamma Bricks release a harmless dry vapour based on essential oils extracted from aromatic plants. The dry vapour spreads quickly in the air to immediately, on a molecular level, encapsulate and neutralize odours originating from smoke and soot damage, water damage, sewage damage, pests, stove fire, protein fire, sweat, chemical spills, decay, mould, moisture, waste water, garbage, food, sweat, urine, faeces, vomit, animals etc.
GENERAL USE
Placed on toilets, around waste containers, under floors, in cavities, waste rooms, smoking rooms, in ventilation ducts, hung up in waste shafts (S.C.S, Simple Clip System), drying/deodorization rooms for contents. Used in vacuum cleaners and for odour removal in pest control services.

RESTORATION
Place one or more Neutrox Gamma Bricks in areas affected by the smell of fire, water damage, etc. The Bricks are used successfully in dehumidification, air purification and ventilation equipment to control odours related to water and fire damage remediation, etc. Place Bricks where air can pass by and release active dry vapour into the air.









Original Neutrox Gamma Bricks have not without reason become a "must have" product in the damage restoration industry. There are many good reasons for that!

Neutrox Gamma Bricks are used successfully in dehumidification, air purification and ventilation equipment to control odours related to water and fire damage remediation, etc. Place Bricks where air can pass by and release active dry vapour into the air.




Vaportek’s SOS oil formulation has been scientifically developed to neutralize odours after fire damage. Place SOS Bricks in your dehumidifiers and ventilation equipment, etc. for full effect. Read more on page 37.



AROMA BRICKS – POPULAR ALTERNATIVE TO THE ORIGINAL NEUTROX GAMMA BRICKS
Contains sensational, high-quality fragrance oils that spread smiles and make happy customers.
Vaportek’s patented and unique odour treatment system sets the standard for environmental and user-friendly odour remediation within the damage restoration industry worldwide.
A scientifically formulated composition of plant extracts form the foundation of Vaportek’s versatile product range.
Vaportek Aroma Bricks are a supplement to the well-known and in the damage restoration industry very popular Neutrox Gamma Bricks, which are based of more than 30 natural essential oils.
Aroma Bricks are available in a range of exquisite scents that please the senses and that contribute positively to neutralizing odours or suppressing the imaginary residual odour that occurs in various insurance claims. Such as the smell of fire, sewage and mould, etc. Or just adding a pleasant scent to a restoration job site – that makes people happy!
Aroma Bricks from Vaportek consist exclusively of high-quality essential oils and specially selected aromas. Aroma Bricks work exactly like our popular Neutrox Gamma Bricks. The exquisite mixture of fine essential oils and fragrances is saturated in a small rectangular brick made of highly absorbent cellulose fibres.
Bricks act as a membrane, that is, when air passes over an Aroma Brick, the oils are released as tiny airborne fragrance molecules and enrich the surrounding air with a scent that is perceived positively by restoration technicians, residents, visitors, etc.
Aroma Bricks – Use your imagination. Can be used wherever malodour is a problem.
In the damage restoration industry, Vaportek Aroma Bricks are a popular supplement to the well-known and widely used Neutrox Gamma Bricks.
Aroma Bricks spreads a high-quality fragrance that makes your customers happy and they will remember you for it.











AROMA BRICKS ARE AVAILABLE IN:
56-1707 Vaportek Summer Orange Bricks
56-1708 Vaportek Lemon Bricks
56-1750 Vaportek Cool Green Bricks
56-1730 Vaportek Berry Bricks
56-1948 Vaportek Ocean Bricks
56-1954 Vaportek Linen Bricks

Carton of 4 x 30 bricks packed in plastic cans (can be mixed as needed)









AROMA BRICKS – A POPULAR ALTERNATIVE TO THE ORIGINAL NEUTROX GAMMA BRICKS
Contains sensational, high-quality fragrance oils that spread smiles and make happy customers.
DAMAGE RESTORATION
Place one or more Aroma Bricks in areas affected by the smell of fire, sewage damage, mould infestation, etc. Place Aroma Bricks in condensing dehumidifiers, adsorption dehumidifiers, centrifugal or axial fans or other type of air mover. Place Aroma Bricks in your vacuum cleaner or directly in the ventilation system and other areas with good ventilation. Use Aroma Bricks in drying rooms for contents such as clothes, furniture, technical equipment, etc. or in a dedicated odour remediation room. Put e.g. Aroma Bricks in large bags together with smelly contents etc.
APPLICATIONS:
• In restrooms.
• Around waste containers/in waste rooms.
• Placed in moloks.
• In ventilation ducts.
• Hung in Vaportek crocodile clips (S.C.S, Simple Clip System).
• Use your imagination. Neutrox Gamma, SOS and Aroma Bricks can be used anywhere and give good results immediately.

TIPS & TRICKS FOR POPULAR USES
PAGES 40-45

Part of the Vaportek "Fresh & Clean Citrus Concept"
Aroma Bricks can be used successfully in dehumidification, air purification and ventilation equipment to control odours related to water and fire damage remediation, etc.
Place the Aroma Bricks where air can pass by and release active dry vapour into the air.

RESULT = FAST, SIMPLE, EFFICIENT AND ECONOMICAL TO USE



NO ONE BEATS THE QUALITY AND EFFECTIVENESS OF THE SENSATIONAL ECOZ AROMAS. OUR CUSTOMERS LOVE WHEN THERE IS ECOZ AROMA IN THE AIR.
DAMAGE RESTORATION

WATER SOLUBLE ODOUR ELIMINATION CONCENTRATE
ECOZ has been specially developed for commercial and institutional use to treat odours on floors, walls and many other surfaces. When washing clothes and textiles in industrial washing machines, ECOZ Linen is added to the final rinse water to remove smoke and other odours. Safe and effective product formulas, containing essential oils, make the ECOZ concentrates the preferred choice among professional cleaning and damage restoration companies, etc.
FEATURES AND BENEFITS
ECOZ water soluble odour neutralizer concentrates use innovative plant-based technology to meet the odour control requirements of floor care and many other cleaning tasks. The ingredients are based on natural essential oils that neutralize bad odours, instead of just masking with chemical/synthetic fragrances. This is one of the reasons why Vaportek’s technology is preferred by professionals within the damage restoration/cleaning industry, as a safe and effective method of solving indoor odour problems.
The non-toxic ECOZ odour neutralizing concentrates have been developed to improve the results of cleaning jobs of all kinds. ECOZ is added directly to the washing or rinse water. ECOZ is 100% compatible with cleaning products and can be added to all kinds of odour-free soaps/cleaning agents. ECOZ is ideal for use in rinse water, in carpet and upholstery cleaning machines as well as all types of floor care applications. The ECOZ products contain 100% natural, fragrant essential oils, and break down a wide spectrum of different odours in a natural way.
SEE DESCRIPTION OF EACH ECOZ AROMA
CONCENTRATE ON PAGE 46 UNDER TIPS & TRICKS





RECOMMENDED PRODUCT USES

Carpet and upholstery cleaning machines, industrial washing machines, floor washing machines, general floor cleaning, cleaning of urinals and toilets, toilet floors, meeting areas, kitchen floors, portable toilets, cleaning of walls, ceilings, etc. after soot and fire damage, waste areas and many other applications.
ECOZ leaves a pleasant, long lingering aroma in the air.
RECOMMENDED DOSAGE
Typically approx. 20-100 ml per 10 litres of washing or rinse water, however depending on the type and intensity of the odour.
NOTE – ECOZ PRODUCTS ARE CONCENTRATES. THEREFORE, ALWAYS USE THE CORRECT MIXING RATIO AND NEVER USE THE PRODUCT CONCENTRATED.
ECOZ is available in the aromas Classic Neutral, SOS, Lemon, Summer Orange and Linen. ECOZ has been developed to control/ neutralize unpleasant odours during cleaning tasks of all kinds. ECOZ is 100% compatible with fragrance-free cleaning concentrates and can be easily added to these cleaning solutions. The aromas (essential oils) do not break down at high temperatures, the product does not foam and has a neutral pH value. ECOZ can also be applied to surfaces using cold foggers, pump sprayers, etc. ECOZ can be used on porous as well as non-porous surfaces, when cleaning floors, walls, carpets, textiles and laundry and as a general room freshener, etc.
Biodegradable.
Non-toxic, non-corrosive. Contains 100% essential oils. Does not stain, does not grease. Removes a wide range of odours. Extremely versatile use.
Available in 1, 5, 20, 208 litres. Available in the aromas: SOS (Smoke Odour Solution) Lemon, Summer Orange, Classic Neutral and Linen.
NEW ALL ECOZ PRODUCTS ARE WITHOUT DYES
ECO-FRIENDLY






ECOZ WATER SOLUBLE ODOUR NEUTRALIZER CONCENTRATE HAS UNLIMITED POSSIBILITIES – ELIMINATES ALL KINDS OF ODOURS!
ECOZ can be dosed in ratios of 1:5 up to 1:128. Adding 20-100 ml ECOZ per 10 litres of rinse water is the standard dosage for these effective odour neutralizing concentrates within the damage restoration industry. Higher concentrations can be used if a stronger aroma is desired or if the product is used as a room freshener. ECOZ can also be used in cold foggers, NAC Power Sprayers or pump sprayers, etc. In carpet and upholstery cleaning machines/washing machines, it is recommended to use ECOZ Linen. When ECOZ is used in washing machines to remove odours from textiles, add approx. 10-80 ml (depending on the laundry load) to the last rinse water. All 5 aromas can be used when washing and deodorizing contents after fire damage, mould damage, water damage, etc.
ECOZ SOS (Smoke Odour Solution) is particularly effective for odour neutralization in all types of smoke and soot damage. Achieve optimal neutralization of all types of smoke odour and avoid odour confusion by using ECOZ SOS odour elimination concentrate in your rinse water, combined with SOS membranes and cartridges in Vaportek’s effective odour neutralization machines, the Restorator and the VaporShark. We call this system synergistic odour control. Also use ECOZ Classic Neutral combined with Neutrox Gamma oil in membranes and cartridges as an alternative to the SOS system. ECOZ Classic Neutral and Neutrox Gamma oil are universally applicable for all kinds of odours. The products can be used together, but also separately if the odour remediation task is not of an extreme nature. ECOZ Lemon can also be used in rinse water when cleaning after a fire etc. as ECOZ Lemon is compatible with dry vapour from Neutrox Gamma and SOS oil.
IN THE CASE OF LIGHT SMOKE ODOUR generally add 20-50 ml ECOZ per 10 litres of water. IF THE SMELL OF SMOKE IS MODERATE add 30-60 ml ECOZ/10 l water. IF THERE IS A STRONG SMELL OF SMOKE add 60-100 ml ECOZ/10 l water.
We also refer to the product label.
ECOZ JUST SMELLS THE BEST!

• Effective deodorant for washing away soot from fire damage.
• Carpet/upholstery cleaning machines.
• In washing and mopping water.
• Hotel rooms.
• Cleaning of toilets/urinals.
• Portable toilets.
• Animal hospitals.
• Waste areas.
• Toilet floors.
• Washing machines.
• Smoking rooms. ... and many more.




PACKAGING SIZE AND ITEM NO:
1 LITRE - 12 PCS. PER BOX
56-1524-1 Classic Neutral
56-1521-1 SOS
56-1526-1 Lemon
56-1527-1 Summer Orange
56-1525-1 Linen
5 LITRE - 4 PCS. PER BOX 56-1524-5 Classic Neutral 56-1521-5 SOS
56-1526-5 Lemon 56-1527-5 Summer Orange 56-1525-5 Linen

20 LITRE - INDIVIDUALLY 56-1524-20 Classic Neutral 56-1521-20 SOS 56-1526-20 Lemon 56-1527-20 Summer Orange
56-1525-20 Linen
208 LITRE - INDIVIDUALLY 56-1524-208 Classic Neutral 56-1521-208 SOS 56-1526-208 Lemon 56-1527-208 Summer Orange 56-1525-208 Linen Made by Vaportek in the USA

BIO-C – BIO-ENZYMATIC ORGANIC BREAKDOWN AGENT AND ODOUR ELIMINATION
Special product from Vaportek, composed of a complex mixture of more than 30 different essential oils (100% natural plant extracts) as well as a suspension of microorganisms and enzymes.
BIO-C CONCENTRATE FOR ORGANIC ODOUR NEUTRALIZATION
Contains essential oils, enzymes and harmless bacterial cultures.
Vaportek’s unique product line of Bio-C water-soluble concentrates quickly, safely and economically eliminates all kinds of odours of organic origin on the spot.
Bio-C prevents clogging of pipes and penetrates smelly stains and discolorations of organic origin on tiles and in grouts in toilets, urinals, bathrooms, etc.
APPLICATION – DAMAGE RESTORATION
Bio-C is the perfect product for biological neutralization and decomposition of all odours originating from water and sewage damage (faeces), moisture and mould damage, urine, body fluids (unattended death), vomit, decay, animals, cigarette smoke, etc.
Bio-C’s formula is unique and is composed of millions of harmless bacterial cultures, enzymes and Vaportek’s special blend of more than 30 essential oils (100% natural plant extracts).
These properties make Bio-C the superior choice when you want to remove and control odours as well as break down organic contamination and deposits.
For breaking down and neutralizing odours arising from water and sewage damage, as well as odours of all other biological origin.
OTHER USES
• Treatment of drains/waste pipes/sewers.
• Toilets/urinals/bathrooms/locker rooms etc.
• In and around waste receptacles, containers, etc.
• Drip systems.
• Waste treatment plant.
• Portable toilets, dry closets, etc.
• Removal of odours in carpets and other textiles.
BIO-C REMOVES BIOLOGICAL/ ORGANIC ODOUR


Bio-C promotes and accelerates the natural organic decomposition process by using a powerful blend of special bacterial cultures as well as a stabilized composition of lipase, cellulase, protease and amylase enzymes.
Bio-C can be used in most industrial environments where odours are to be removed, and is particularly effective for removing odours in grease separators, waste areas, drains/sewers and septic systems.
APPLICATION METHODS
Spray directly on the odour source with a hand sprayer, pressure sprayer, NAC Power Sprayers or special automatic pump/nozzle systems. Feed Bio-C directly into drains/waste pipes/grease separators etc. using dosing pumps.
Contact NAC Europe for more info on dosing systems.
REMOVES/DECOMPOSES ODOURS FROM
Urine/faeces, organic household waste, hospital waste, smoke, sewage, grease separators, decay, vomit, moisture, mould, sweat, milk, diesel, animals, blood, unattended death cleanup, oil and all other odours of organic origin.
BIO-ENZYMATIC ORGANIC BREAKDOWN AGENT AND ODOUR ELIMINATION






BIO-C – BIO-ENZYMATIC ORGANIC BREAKDOWN AGENT AND ODOUR ELIMINATION
Special product from Vaportek, composed of a complex mixture of more than 30 different essential oils (100% natural plant extracts) as well as a suspension of microorganisms and enzymes.
SPECIFICATIONS
• water-soluble concentrate.
• Shelf life approx. 12 months.
• Non-flammable and non-corrosive.
• Works immediately on contact and for a long time after application.
• Mixing ratio:
Can be used concentrated and up to 1:150 depending on application. For normal use with e.g. a pump sprayer, 1:5 to 1:20 dilution is recommended.
• Multi-enzymatic.
• Contains harmless bacterial cultures/strains.
• Contains Vaportek’s unique and harmless odour neutralizing additive (essential oils).
• Does not tolerate frost.
• Biodegradable.
• Packaging sizes:
1 litre, 5 litres, 20 litres and 208 litres.
BIO-C:
56-1523-1 Bio-C - 1 litre
56-1523-5 Bio-C - 5 litres
56-1523-20 Bio-C - 20 litres
1 When the essential oils come into contact with the odour, plant oil molecules will react with the odour molecule by encapsulating and neutralizing it. The process works immediately, and is not a masking of the bad odour, but a real odour neutralization.
2 Bio-C contains an advanced suspension of harmless bacterial cultures and enzymes which break down smelly organic matter and convert the organic substances into water and carbon dioxide. The source of the bad odour is thus permanently removed.

BIO-C REMOVES BIOLOGICAL/ORGANIC ODOURS

APPLICATIONS
• Damage restoration
• Hospitals and nursing homes
• Schools, gyms, sports arenas
• Housing associations
• Slaughterhouses
• Pest control
• Treatment plant
• Rendering plants, fishing industry, etc.
• The hotel and restaurant industry, etc.



BIOHAZARD



SPECIALLY DEVELOPED FOR USE IN VENTILATION SYSTEMS, DEHUMIDIFICATION AND DRYING SYSTEMS, IN FRONT OF AIR FANS, ETC.
Adjustable aluminum lid for dosing dry vapour (on both ends of the cartridge).
Stabilizer that holds the cartridge in the desired position.
Stativ, der holder patronen i den ønskede stilling
ODOUR CONTROL FOR LARGE CLAIMS
Place the HDS cartridge in the ventilation system or in front of air blowers/fans, as first aid for odour problems/complaints after a fire in larger buildings such as in warehouses, shopping malls, factory halls etc.

Openings for air flow.
Åbninger til luftgennemstrømning


neutrox gamma oil
HDS-CARTRIDGES ARE AVAILABLE IN:

Item no. 56-1353 HDS cartridge Neutrox Gamma standard.
Item no. 90-2200-85 HDS cartridge SOS oil.
Item no. 90-2200-86 HDS cartridge Lemon oil.
SPECIFICATIONS

Place e.g. HDS cartridges in larger adsorption dehumidifiers for odour control.
Packaging size: Box with 6 cartridges.
Dimensions: 14.6 cm in height x 9.5 cm in diameter. Effective for up to 8 weeks with normal use.
Treats areas of up to 1,800 m².
Adjustable aluminum lid ensures precise dosing of deodorizing dry vapour.
Accessories: reusable cartridge stabilizer, no. 90-2201. OZONE- AND AEROSOL-FREE METHOD = MAXIMUM SAFETY FOR USERS




SPECIALLY DEVELOPED FOR USE IN VENTILATION SYSTEMS, DEHUMIDIFICATION AND DRYING SYSTEMS, IN FRONT OF AIR FANS, ETC.
PURPOSE
Vaportek’s HDS cartridge is designed to provide passive odour remediation specifically for use in air conditioning/ventilation systems. It is also used in high-performance dehumidification, air purification and drying systems for damage restoration after e.g. water and fire damage. The cartridge contains a patented membrane which releases a harmless, odour neutralizing dry vapour based on an advanced mix of more than 30 different plant oils. Vaportek has used this formula for odour remediation in the damage restoration industry, odour control in food production, waste treatment, healthcare, in offices, factories, hotels and in private homes worldwide for more than 45 years.
PLACEMENT
The stand-alone cartridge can be placed in any air handling system. For maximum effect, the cartridge is placed lengthwise, and the adjustable caps at the ends must be fully or partially opened to allow air to pass through the cartridge. The cartridge can be held in place with a stabilizer. Where air currents are very strong, the cartridge can be secured using duct tape or doublesided tape. The cartridge can also be placed in front of air blowers/fans etc. to achieve quick and effective odour remediation, for example after fire damage or when cleaning carpets and the like.
Vaportek’s HDS cartridge provides immediate and powerful odour control in areas where most other systems fail. The deodorizing dry vapour quickly penetrates the porous surfaces it comes into contact with.


SUDDEN ODOUR CONTROL
The stabilizer is used to hold the cartridge in the desired position. Turn the cartridge’s adjustable end pieces to the desired position and insert the cartridge horizontally into the stabilizer. Place the stabilizer in an air duct or in front of an exhaust shutter where air can flow through the cartridge.

By placing the Heavy-Duty Standalone cartridge in a stabilizer which you then connect to an air mover, you produce both active dry vapour for odour removal and air for drying after water and fire damage. ODOUR REMOVAL AND DRYING SIMULTANEOUSLY

Tip: Use ECOZ liquid in your cleaning/rinse water when cleaning fire damage.







ECO-FRIENDLY ODOUR CONTROL WITH PURE "PLANT ENERGY"

Since Vaportek was founded in 1979, the company’s unique Neutrox Gamma oil has been the backbone of the company’s global success and the scientifically formulated mix of complex natural oils has yet to be duplicated, simply because it is not possible!
The Vaportek technology is a unique method of safe, effective and simple odour removal. The method has, worldwide, set a new standard for environmentally and user-friendly odour remediation within the damage restoration industry.
A scientifically formulated and patented composition of more than 30 different and 100% natural aromatic plant extracts form the foundation of Vaportek’s versatile product range. This complex mix of essential oils is called Neutrox Gamma and was developed in the late 70s by a reputable American pharmaceutical manufacturer for the safe and effective neutralization of odours in the American healthcare system. Today, Vaportek is used with great success in many different industries.
The Neutrox Gamma oil is hermetically sealed in a special plastic membrane. When air is passed over the membrane, using the Vaportek machines built-in fan, the oil diffuses through the membrane and is released into the air as an active dry vapour. The plant oil molecules of the dry vapour are extremely active. They quickly spread to the entire treatment area and effectively penetrate porous surfaces, such as wood, concrete, wallpaper, plaster, bricks, insulation materials, textiles, etc. and settles on non-porous surfaces to quickly and effectively encapsulate and neutralize or modify odours at a molecular level. Odours from fire



and soot damage, nicotine, urine, mould, sewage, faeces, stove fire, burned-on food, protein fires, sweat, vomit, food, decay, pets and all other odours of organic origin.
THIS NEUTRALIZATION PROCESS IS CALLED "ZWAARDEMAKER PAIRS"
Intense research into the unique essential oils, which are also used for the development of pharmaceuticals, has shown that many of these oils possess the ability to neutralize odours if you pair/combine an essential oil with a given odour molecule.
The formula of Vaportek’s complex blend of these oils is carefully composed based on the fact that specially selected essential oils will neutralize odours of various origins.
Together with the Neutrox Gamma oil in the membrane/cartridge, we recommend using ECOZ liquid odour elimination concentrates Classic Neutral, Lemon or Summer Orange.












ECO-FRIENDLY ODOUR CONTROL WITH PURE "PLANT ENERGY"
Vaportek – Unlimited Possibilities – Eliminates All Kinds of Odours!
The SOS oil is scientifically formulated and specially developed for odour remediation after fire and smoke damage. Vaportek offers this brilliant mix of essential oils as an alternative to the original and popular Neutrox Gamma oil. SOS smells pleasant, yet is powerful and effective, making it an ideal choice for neutralizing smoke odours in private homes and other areas where people stay, while improving the working environment for damage restoration technicians. SOS is not a replacement for Neutrox Gamma oil, but must be seen as an effective alternative for all types of smoke and soot damage. The SOS oil is available as membranes for the VaporShark, as cartridges for the Restorator, SOS Bricks and HDS cartridges for e.g. odour treatment of ventilation ducts.
See pages 16-18 for a more detailed explanation of how essential oils neutralize odours according to the Zwaardemaker Pairs method.
"We use the SOS oil with great success for all types of fire damage. The customers are very satisfied, and everyone appreciates the mild aroma that the SOS oil releases."
Allan Nielsen, Branch Manager - Polygon
A/S, Denmark




IDEAL FOR:
Protein fires
Pot/pan fire, burnt and charred meat and most fires where cellular tissues are involved.
Wood/paper fires
Fire in rooftops, chimney fire, explosion fire and fire in buildings and in general where wooden structures are involved, etc.
Synthetic fires
Carpets and upholstery, fire in electrical installations and generally where plastics are burnt.
Cigarette smoke/Nicotine smell
Private homes, apartments, restaurants, waiting rooms, vehicles and anywhere tobacco smoke is a problem.
Together with the SOS oil in the membrane/ cartridge, we recommend using ECOZ liquid odour elimination concentrates SOS, Lemon or Summer Orange.
ARE NOW AVAILABLE WITH







With the Fresh & Clean Citrus Concept, we pay tribute to Vaportek’s fantastic ability to formulate products that work and make people happy. Citrus scents are associated with purity and freshness. Especially in the damage restoration industry, the scent of cleanliness and freshness is popular! The Fresh & Clean Citrus Concept is a sure success!
Since Vaportek was founded in 1979, the company’s unique Neutrox Gamma oil has been the backbone of the company’s global success and the scientifically composed and complex oil blend has yet to be copied or imitated, simply because it is not possible. Along with the also scientifically formulated SOS oil (Smoke Odour Solution), these two oil blends are popular in the damage restoration industry and create convincing results when stubborn odours from fire and other foul-smelling damages need to be controlled and neutralized.
As a fresh and fragrant initiative, Vaportek pays tribute to the scent of the ever-popular citrus fruits in its Fresh & Clean Citrus Concept. Fresh & Clean Citrus Concept is available in a Lemon and a Summer Orange version.
The popular Vaportek Lemon scent has always been one of our bestsellers. The Lemon and Summer Orange versions are available as membranes for VaporShark, cartridges for Restorator, as Aroma Bricks and as ECOZ odour neutralizer concentrate.
USE OF LEMON MEMBRANES AND CARTRIDGES IN THE VAPORSHARK AND THE RESTORATOR
ECOZ Lemon has been one of our bestsellers among the ECOZ products for several years, but also as membranes and Aroma Bricks, simply because Vaportek’s Lemon products smell fantastic! The reason for the fresh, clean and effective citrus aroma is simply the use of genuine essential oils from several different citrus fruits. In technical terms, ECOZ Lemon is called a top note
fragrance. Top note fragrances are green scents. They are fresh and based on notes from citrus fruits such as lemon, bergamot, orange, mandarin, grapefruit etc.
Lemon membranes and cartridges are used separately for lighter odour damage, where they will refresh the treated rooms with a natural and catchy, clean and fresh citrus scent. Lemon membranes can also be used in combination with SOS or Neutrox Gamma membranes, on severe odour damage where the primary odour neutralization comes from the Neutrox Gamma or SOS oil, but where Lemon will give an invigorating fresh hint of catchy citrus scent, which is appreciated by the customers. Lemon membranes also act as an antiseptic.
USE OF SUMMER ORANGE MEMBRANES AND CARTRIDGES IN VAPORSHARK AND RESTORATOR
To enrich the selection of wonderful Vaportek aromas, Vaportek has introduced another lovely and fresh top note fragrance, Vaportek Summer Orange. Vaportek has very successfully captured the scent of freshly squeezed oranges. Summer Orange membranes and cartridges are fresh, bubbly and warm and the scent is provided by tangerine, orange, blood orange, grapefruit etc. Neither Lemon nor Summer Orange membranes/cartridges replace the use of Neutrox Gamma or SOS membranes/cartridges, as these are scientifically formulated to neutralize odours within professional damage restoration. But they can be used in combination with theese, or seperately after treatment with Neutrox Gamma or SOS, to add to the job a fresh hint of citrus scent that customers will appreciate.
It is scientifically proven that: Essential oils from citrus fruits make people happy!
Our customers love Vaportek’s citrus products Lemon and Summer Orange, available as membranes, cartridges, Aroma Bricks and ECOZ concentrate. These can be used separately or in combination with each other, depending on the intensity of the smell. About some of the most commonly used citrus oils in the above products it is said:

GRAPEFRUIT: Gives new energy and good mood - sharpens concentration
LEMON: Gives good mood and energy - helps you to focus
BERGAMOT: Gives new energy and has a refreshing effect
ORANGE: Gives a good mood and has a refreshing effect
MANDARIN: Gives energy and good mood

Result: Your customers will be happy when they feel the fresh breeze of Lemon or Summer Orange




MEMBRANES FOR VAPORSHARK:
- SOS (Smoke Odour Solution)
- Neutrox Gamma
- Summer Orange
- Lemon
- See also page 21

CARTRIDGES FOR RESTORATOR:
- SOS (Smoke Odour Solution)
- Neutrox Gamma
- Lemon
- Summer Orange
- Other variants: See page 22










BESTSELLER PRODUCTS FROM OUR FRESH & CLEAN CITRUS CONCEPT Lemon and Summer Orange as ECOZ concentrate and Aroma Bricks. Based on genuine essential oils for effective and fragrant results that your customers will love!

GET THE MOST OUT OF YOUR VAPORSHARK
Use Neutrox Gamma or SOS alone, or in combination with a Lemon or Summer Orange membrane.
GET THE MOST OUT OF YOUR RESTORATOR
Use Neutrox Gamma or SOS cartridges. Or try a Lemon or Summer Orange cartridge from our Fresh & Clean Citrus Concept.





Neutrox Gamma Bricks are one of our bestsellers for the damage restoration industry in Europe.
All types of fires – burnt synthetic materials, protein fires (cellular tissue), burnt wood and other building materials, etc.
Neutrox Gamma Bricks can be placed anywhere where the smell of fire is a problem. Place Neutrox Gamma Bricks in particularly exposed places with odour nuisances. The greater the airflow, the better Neutrox Gamma Bricks can release the essential plant oils as an active odour neutralizing dry vapour. Therefore, place Neutrox Gamma Bricks in places with drafts or good air ventilation, or directly in ventilation ducts.
In case of odour problems in larger rooms, place an air mover or similar in the room and mount one or more Neutrox Gamma Bricks on the intake or exhaust side, just somewhere in the fan’s air flow or directly in the duct hose, if one is fitted. This will release active Neutrox Gamma dry vapour and suppress/neutralize the unpleasant smell of soot/smoke. You can optionally attach a Neutrox Gamma Brick to our S.C.S (Simple Clip System) and attach the S.C.S chain on your air mover (see picture page 14).
For subsequent dehumidification of fire extinguishing water, Neutrox Gamma Bricks can be installed in condensation or adsorption dehumidifiers or air blowers/ventilation equipment etc. for continuous odour treatment.
All types of moisture and water damage where odour is a problem. Sewage, waste water, process water, biologically contaminated water, etc.
Neutrox Gamma is simply placed where there is a smell of e.g. sewage or other waste water is a problem. If necessary, first spray the contaminated surfaces with Vaportek Bio-C, which breaks down organic odours with the help of essential oils, enzymes and microorganisms. Also place Neutrox Gamma Bricks in the Vaportek S.C.S (Simple Clip System) and attach this to your ventilation equipment such as centrifugal or axial fans.
During the dehumidification process, Neutrox Gamma Bricks can be installed in dehumidifiers or air blowers/ventilation equipment etc. for continuous odour treatment.
GET HAPPY CUSTOMERS
PAGES 26-29


USE FOR FAECES, VOMIT, URINE, ROTTEN MEAT (DEAD BODY SMELL) AND ALL OTHER ODOURS OF ORGANIC ORIGIN
First spray all surfaces with Vaportek Bio-C, which breaks down organic/biological contamination and place Neutrox Gamma Bricks in the area or in your air handling equipment etc.
REMOVAL OF IMAGINARY RESIDUAL ODOUR
In cases where an imaginary residual odour occurs after a finished remediation job, this can often be eliminated with the help of Neutrox Gamma Bricks or Aroma Bricks. An imaginary residual odour is an odour which is only perceived by the customer and is not really an odour in itself. By giving the customer a Neutrox Gamma Brick or an Aroma Brick, the problem can be solved.
Use your imagination and you will find that Neutrox Gamma Bricks are super for providing first aid for odours – especially in situations where it needs to be done quickly. The result will always be satisfied customers who quickly notice and appreciate that you have made an effort to remove the unpleasant smell.
NEUTROX GAMMA BRICKS REMOVE/NEUTRALIZE
ALL KINDS OF ODOURS!
Neutrox Gamma Bricks contain active Neutrox Gamma oil which removes/neutralizes a very wide spectrum of different odours originating from fire and soot damage, mould, mildew, sewage, foul-smelling industrial waste water, decay (incl. unattended death), organic household waste (incl. leachate), vomit, urine, sweat, pests, pets, smell of stove fire and many more.




GET THE MOST OUT OF YOUR VAPORTEK PRODUCTS AND GET HAPPY CUSTOMERS
NEUTROX GAMMA BRICKS CAN BE USED EVERYWHERE!
Place Neutrox Gamma Bricks in the supplied aluminum trays and set up in homes and buildings to immediately control odours. Place Neutrox Gamma Bricks in condensation dehumidifiers, adsorption dehumidifiers, side channel compressor turbines, centrifugal fans, axial fans, HEPA air cleaners, as well as any other technical damage restoration equipment that generates air currents.
Place Neutrox Gamma Bricks in ventilation ducts. Place Neutrox Gamma Bricks in hard-to-reach places such as under floors, crawl
spaces, attics, between floors, cavities, etc. The number of Neutrox Gamma Bricks to be used for the individual tasks depends on the type of smell, the intensity of the smell and the size of the room.
There are no limits to where you can use this small but extremely effective product, which gives you full power with active dry vapour from Neutrox Gamma oil.

If you want to enrich the air with a mild and pleasant scent, Aroma Bricks can be used in exactly the same way as Neutrox Gamma Bricks!






Neutrox Gamma Bricks are used successfully in dehumidification, air purification and ventilation equipment to control odours during water and fire damage remediation, etc. Place Neutrox Gamma Bricks where air can pass by and release active Neutrox Gamma oil, which is converted into odour neutralizing dry vapour.
Control of odour, e.g. when dehumidifying general moisture and water damage, as well as damage caused by fire extinguishing water.





Place Neutrox Gamma, SOS or Aroma Bricks in the dehumidifier’s air inlet or outlet


Can also be placed in tubes

















Place Neutrox Gamma, SOS or Aroma Bricks in the air intake hose of the Drymatic II (picture 1) or place them in mats when drying floors or walls with Drymatic mats together with the Boost Bar (picture 2).
Control of odour, e.g. related to fire and water damage, etc.


Clip the Neutrox Gamma, SOS or Aroma Bricks into the Vaportek S.C.S (Simple Clip System) and mount it on the blower’s air inlet or air outlet.



Control of odour, e.g. related to fire and water damage.


Clip the Neutrox Gamma, SOS or Aroma Bricks into the Vaportek S.C.S (Simple Clip System) and mount it to the front or back of the floor fan.






GET THE MOST OUT OF
Control of odour, e.g. related to fire and water damage.






Clip the Neutrox Gamma, SOS or Aroma Bricks into the Vaportek S.C.S (Simple Clip System) and mount it on the blower’s air inlet or air outlet. Also put Neutrox Gamma, SOS or Aroma Bricks in the duct hose of the axial fan.
A little more inspiration for other uses.



Place fragrant Lemon or Summer Orange Aroma Bricks in your van. Your customers will notice.
"Little things make a big difference". Remember that the sense of smell is linked directly to the area of the brain called the limbic system, which controls memory, emotions and instinctive behaviour. If it smells clean and good when you have finished your damage restoration job, it is perceived by the customer as positive. It provides positive branding of your company, will improve your professional image and thus strengthen your competitiveness. IT IS A FACT.

Use Neutrox Gamma Bricks for pest odour removal. If necessary, spray the area with Bio-C first.

Use Neutrox Gamma Bricks or Aroma Bricks for pet odours. E.g. urine, wet dog, faeces, etc. If necessary, spray with Bio-C first.


Attach Neutrox Gamma or Aroma Bricks to your dehumidification equipment and leave a hint of fragrance that your customers will love and remember.

Fires in apartments often cause odours in stairwells. Place Neutrox Gamma Bricks in different places in the stairwell, and avoid neighbor complaints.
Make your customers happy. Give them a free fragrant Aroma Brick in an EZTwist when you’re done with the damage job. They’ll remember you for that.
Control of odour, e.g. related to mould remediation, fires etc.


Place a Neutrox Gamma, SOS or Aroma Brick in the air intake or outlet.













Control of odour in ventilation ducts with odour problems and/or control of odour in rooms that are supplied with air via the ventilation duct.
Place one or more Neutrox Gamma Bricks or place a Heavy-Duty Standalone cartridge (HDS) in the ventilation duct. In this way, you will remove/control odours originating from the ventilation duct and at the same time also treat rooms/premises that are supplied with air from the same ventilation duct. You use the ventilation duct to spread/diffuse active dry vapour to several rooms with unpleasant odours.











Professionelle støvsugere
GET THE MOST OUT OF YOUR VAPORTEK PRODUCTS AND GET HAPPY CUSTOMERS
kendt
Control of bad odours from vacuum cleaners.
Nilfisk VP930 er den pålidelige partner til krævende rengøringsopgaver på hoteller, skoler, kontorer og hospitaler. Robust og stabil med stor støvsugerpose, der rummer 15 liter. Det gennemtænkte design optimerer luftstrømmene og reducerer energitabet til et absolut minimum, samtidig med at det gør VP930 til en af de mest lydsvage professionelle støvsugere i verden.
Resultatet er fremragende sugestyrke og imponerende holdbarhed. Det er grunden til, at vores kunder holder sig til VP930 år efter år.
When vacuuming in the damage restoration industry, an un pleasant smell can arise from the vacuum cleaner. Place one or more Neutrox Gamma Bricks or Aroma Bricks next to the vacuum cleaner bag or near the HEPA filter on the air outlet.



• Meget lavt støjniveau
Enestående holdbarhed med robust stålbeholder
Kvalitetskomponenter
Stor kapacitet med 15 liter støvpose
HEPA H13-filter som standard

Parkeringsløsning som standard 2 hastigheder på flere modeller
Neutrox Gamma Bricks or Aroma Bricks will transform any bad smell into a pleasant scent that will be perceived positively by your surroundings.
Effective odour control – prevention in cars, motorhomes, boats, caravans, holiday homes etc.









Place Neutrox Gamma Bricks or Aroma Bricks in cupboards, under car seats etc. in the supplied aluminum trays or split a Brick in half and place them in an EZ-Twist. Hang the EZ-Twist using the Velcro system.









DESCRIPTION OF ECOZ ODOUR ELIMINATION CONCENTRATE. GET THE MOST OUT OF VAPORTEK PRODUCTS AND GET HAPPY CUSTOMERS
Essential oils from citrus fruits. Lemon, bergamot, grape, lime etc. Lovely natural scent of fresh citrus. The ECOZ Lemon version is among our customers’ absolute favorites and is part of the new "Fresh & Clean Citrus Concept". ECOZ Lemon does not smell like all other synthetic citrus fragrances. ECOZ Lemon is concentrated and contains 100% essential oils from selected citrus fruits. The ECOZ Lemon version is popular both among restoration technicians and not least among home owners/ residents who enjoy the scent of fresh, clean and natural citrus fruits in their homes. When it smells of ECOZ Lemon, it smells CLEAN.
To enrich the ECOZ products with another fresh, natural and energizing citrus scent – we introduce ECOZ Summer Orange, which together with ECOZ Lemon constitutes NAC’s new "Fresh & Clean Citrus Concept". Vaportek has very successfully captured the scent of freshly squeezed oranges. ECOZ Summer Orange is composed of tangerine, orange, blood orange and grapefruit etc. Summer Orange smells just lovely, creates positive energy, fresh air and a good mood. Use Summer Orange in your rinse water when washing after fire and sewer damage, etc., when cleaning contents, or spray ECOZ Summer Orange with your ULV (cold) fogger and much more. ECOZ Summer Orange is already a hit with many customers. When it smells of ECOZ Summer Orange, it smells CLEAN.
A powerful mix of many different and specially selected essential oils. ECOZ Classic Neutral is a classic and its strength and power from specially selected essential oils make it a safe choice for any odour challenge. Like the other ECOZ versions, Classic Neutral is a powerful concentrate where you get value for your money. ECOZ handles all odours from fire/soot, unattended death cleanup, sewer, etc. and will never let you down. Classic Neutral’s clean and slightly spicy aroma consists of, among other, eucalyptus, spearmint and other fragrant essential oils. Classic Neutral is a safe choice for all odour problems.





Especially suitable for all types of wood/paper/protein and synthetic fires. A selected mix of essential oils for various fire and soot damages, etc. Superb product for neutralizing smoke and soot odours. ECOZ SOS is simply an ingenious and scientifically formulated concentrate consisting of selected essential oils, which react particularly effectively to odours from fire and soot. A favorite with many customers when cleaning after fire and soot damage. SOS smells mildly of cinnamon, citrus and other exciting fragrance nuances. SOS leaves a very pleasant and mild scent.
Valued and super effective product for removing all kinds of odours in textiles. Leaves a nice and mild scent of freshly washed clothes/linen. Add ECOZ Linen to your washing machine or to your carpet- and upholstery cleaning machine. ECOZ Linen effectively removes odours from fire and smoke, mould, sweat etc. Linen leaves a pleasant scent of freshly washed clothes/linen.



Which ECOZ products should I choose? If you are unsure of your choice, get a free sample pack of small 250 ml ECOZ bottles sent to you, or mix a carton (12 x 1 litre) at an introductory price and test the products on your odour remediation tasks. YOU’LL BE THRILLED.




GET THE MOST OUT OF VAPORTEK PRODUCTS AND GET HAPPY CUSTOMERS
VAPORTEK ECOZ ODOUR NEUTRALIZER CONCENTRATES
ECOZ odour neutralizer concentrates are among our most popular products within professional damage restoration, and there are several reasons for this. Namely efficiency and aromas that your customers will simply love!
All different ECOZ versions are composed of complex essential oils, which are designed to neutralize odours and leave a longlingering aroma in the air. If you clean after e.g. a fire damage and use an ECOZ product in your rinse water, your efforts will immediately be noticed, because you spread a positive scent that your surroundings will love and notice. Vaportek’s ECOZ products are unquestionably the most advanced and best smelling odour neutralization liquid concentrates in the damage restoration industry.







The smell of smoke and soot after a fire evokes bad memories for business and homeowners who have suffered a loss, but as soon as you start cleaning up after a fire or water damage and you use an ECOZ product, frustration turns into a smile! Not only do ECOZ products smell great, they also effectively remove odours.
When washing/cleaning after fire damage, two buckets are often used. A bucket with fragrance-free alkaline detergent and a bucket with clean rinse water. We recommend adding 20-100 ml ECOZ concentrate per 10 litres of rinse water, depending on the type and intensity of the odour.
The smell of smoke/soot on the surface will be neutralized by the rinse water when a suitable ECOZ product is added. The ultra-small molecules of essential oils will penetrate the surface and neutralize the smell according to the Zwaardemaker Pairs method. See pages 16-18. The surface will appear clean, free of bad odour and without greasy residues with a hint of nice ECOZ fragrance. Subsequent surface treatment in the form of paint can be carried out without problems.
For strong, medium and mild smoke/soot odours use ECOZ SOS or ECOZ Classic Neutral. For milder odours use ECOZ Lemon or ECOZ Summer Orange. If necessary, you can subsequently use a Restorator or VaporShark with membranes/ cartridges that contain the same aroma as the ECOZ products. We call it synergistic odour control. See page 31 for further details.

Cleaning solution with alkaline detergent



GET THE MOST OUT OF VAPORTEK PRODUCTS AND GET HAPPY CUSTOMERS
ECOZ products are also popular for use in ULV cold foggers. Always dilute the ECOZ products with water and in the correct mixing ratio. Use ECOZ in ULV cold foggers for odour treatment in buildings and rooms after fire and smoke damage, in ventilation ducts, crawl spaces, trailers, etc. Never use ECOZ concentrated!








ECOZ odour neutralizer concentrates and other chemicals from NAC can easily be applied with a Power Sprayer. The NAC Power Spray series consists of a series of professional electric sprayers that use long-lasting magnetic pumps that deliver extremely good operational reliability, constant pressure with perfect and uniform spray patterns. The electric sprayers work as if they were made for the damage restoration industry, and ensure fast and optimal results with all NAC’s chemical products. At NAC Europe, we know that working with tools that make the application process simple, fast and efficient is a great motivation factor for every damage restoration employee, thereby creating job satisfaction and achieving the best and most profitable results. As they say "Good tools are half the job".













GET THE MOST OUT OF VAPORTEK PRODUCTS AND GET HAPPY CUSTOMERS
ECOZ concentrates are popular for restoring contents. Add ECOZ Lemon, Summer Orange or Classic Neutral to your cleaning or rinse water when washing/cleaning all kinds of contents that can withstand water, such as crockery, dolls, applied art, decorative home interiors, porcelain, ceramics, lamps, household appliances, white goods, etc.
Contents that are returned to the homeowner must not smell of smoke. Therefore use Vaportek’s effective ECOZ products to remove odours and add a scent that the customer is guaranteed to be pleased with. Happy customers mean everything.



Add ECOZ Linen to your washing machine. ECOZ Linen effectively removes smoke and soot smell, and leaves a clean smelling scent. If you prefer a fragrance-free odour remover for clothes, we recommend our revolutionary OdorKlenz Laundry Additive, which neutralizes and removes all odours and chemicals from washable textiles using natural earth minerals. Patented. ECOZ Linen and OdorKlenz are the market’s best solutions for odour treatment of textiles. We recommend that the products are used separately.





After fire and other odour damage. Add a little ECOZ Linen, Classic Neutral, Summer Orange or Lemon to the rinse water container of your carpet- and uphol stery cleaning machine. Your carpets and furniture will be free of bad odour with a hint of lingering ECOZ Linen aroma.




GET THE MOST OUT OF VAPORTEK PRODUCTS AND GET HAPPY CUSTOMERS
BIO-ENZYMATIC ORGANIC BREAKDOWN AGENT AND ODOUR ELIMINATION
The complex mix of different essential oils and the content of specially selected micro-organisms and enzymes contribute to a rapid and complete breakdown of odours of biological/organic origin. Eg. odours from sewage, faeces, dead body, organic household waste, urine, pests, vomit, etc.
Apply Bio-C to all contaminated surfaces with watering cans, ULV (cold) foggers, NAC Power Sprayers, pressure sprayers, etc. or feed Bio-C into grease separators/traps, drains etc. using dosing technology. Contact NAC regarding technical questions about dosing technique.
1 When the plant extracts come into contact with the odour, plant oil molecules will react with the odour molecule by encapsulating and neutralizing it. The process works immediately, and is not a masking of the bad odour, but a real odour neutralization.
2
Bio-C contains an advanced suspension of harmless bacterial cultures and enzymes which break down smelly organic matter and convert the organic substances into water and carbon dioxide. The source of the bad odour is thus permanently removed.
Spray Bio-C on affected surfaces. Clean and disinfect if necessary before treatment with Bio-C. Contact NAC for precise guidance if you are in doubt.
Remove the pest, if possible. Spray with Bio-C and place Neutrox Gamma Bricks as additional prevention of odour nuisances. If necessary, disinfect the area before treatment with Bio-C.



3
BY
Remediation of odours after an unattended death can be very complicated and extensive, but Bio-C is part of NAC’s protocol for removing dead body odours. Contact NAC for further information about recommended products including Bio-C which can be used for an unattended death cleanup. Remediation of odours from dead body smells is described in NAC’s new Odour Management Concept.




GET THE MOST OUT OF VAPORTEK PRODUCTS AND GET HAPPY
Bio-C breaks down and removes malodours from surfaces that have been in contact with organic waste, such as meat, fruit, vegetables, flowers, bread, milk and cheese, etc. Bio-C is sprayed directly on these surfaces, which are typically found in waste areas. Bio-C’s essential oils will immediately ensure effective odour reduction and the effective microorganisms and enzymes will then break down the waste and convert it into water and carbon dioxide (CO2), the same as happens in nature.
Bio-C’s active bacteria and enzymes ensure complete odour removal and breakdown of grease accumulations in grease separators, drains and other installations that come into contact with waste water from the food industry, commercial kitchens, restaurants, etc. Dosing systems can be installed. Contact NAC Europe for further information.
Bio-C can be injected directly into hoods/exhaust systems in the food industry, commercial kitchens, restaurants, etc. with special nozzle/pump dosing systems. Bio-C breaks down/removes fat and thus keeps these exposed places completely free of accumulations of frying fat, frying oil and other contaminants and thus also free of unpleasant odours. The dosing system can be installed. Contact NAC Europe for further information.
Cleaning/odour removal of particularly unsanitary and messy appartments can be carried out with various Vaportek products. Bio-C can be sprayed directly on all porous as well as hard surfaces, plastered walls, wallpaper, concrete, wood, carpets, curtains, tiles, etc. Clean thoroughly first. In this process, you can also use Vaportek ECOZ concentrates in the rinse water or directly together with fragrance-free detergent in the cleaning process itself.
Bio-C breaks down and removes urine odours from humans, cats, dogs and other domestic animals. Effectively removes urine odour from bed linen, carpets and all other materials and surfaces. Removes urine odour in and around urinals and is particularly effective in breaking down urine odours from porous grouts around urinals, toilets, etc. Contact NAC Europe for specific information on urine odour removal as it may be necessary to combine Bio-C with other odour remediation products included in NAC ´s new Odour Management Concept.





GET THE MOST OUT OF VAPORTEK PRODUCTS AND GET HAPPY CUSTOMERS
The Restorator is a unique, compact and very versatile odour treatment machine that helps you remove odours immediately and make your customers happy. The Restorator is an indispensable tool for thousands of damage restoration companies worldwide.
The Restorator is excellent to use immediately after the fire is out. Victims, neighbors etc. are frustrated by the strong smell of soot. The Restorator alone or combined with other Vaportek products such as Neutrox Gamma Bricks, SOS Bricks and ECOZ concentrates, will help to reduce the strong and unpleasant smell of smoke and soot, with the result that odour complaints are reduced or completely avoided.




The Restorator is particularly suitable for the permanent removal of unpleasant odours after a fire etc. and can be used during the entire remediation process. The standard procedure is to wash all surfaces with alkaline detergent and use ECOZ odour neutralizer concentrate in your rinse water. Then you can use a Restorator which will remove any residual odour after cleaning. We recommend that you use a cartridge with SOS oil (Smoke Odour Solution) or with Neutrox Gamma oil in the Restorator. For lighter odour remediation, our fresh Lemon and Summer Orange cartridges from the Fresh & Clean Citrus Concept are very popular.











GET THE MOST OUT OF VAPORTEK PRODUCTS AND GET HAPPY CUSTOMERS
Popular machine for removing odours in cars, motorhomes, caravans, holiday homes, boats and the like. If necessary, apply/wash first with Bio-C or ECOZ concentrate on textiles and hard surfaces.


Place the Restorator in front of the air intake of an air mover and effectively spread the odour neutralizing active dry vapour from the Restorator to a larger area.

The Restorator can be used for odour treatment of furniture and textiles. The tiny essential oil molecules from the active dry vapour will quickly penetrate materials and textiles. We recommend using Vaportek Lemon or SOS cartridges for this purpose.
The Restorator is ideal for odour treatment of hotel rooms, if e.g. a smoking ban is not observed or for the removal of all other unpleasant odours in hotel rooms such as sweat, vomit, urine, food etc. Smelly hotel rooms cannot be used and cost a lot of money every night the room is not rented out. If necessary, spray with Bio-C first directly in places where the source of the smell can be detected. First remove the source of the smell, e.g. vomit on carpets, clean the area and then spray the area with Bio-C. Then use the Restorator, which very quickly and effectively removes/ eliminates the smell in the entire room with the active dry vapour. Hotel maids worldwide are enthusiastic about the ability of the Restorator and Bio-C to quickly, efficiently and ECO-friendly neutralize odours in hotel rooms.







GET THE MOST OUT OF VAPORTEK PRODUCTS AND GET HAPPY CUSTOMERS
VAPORSHARK
Particularly powerful and effective machine for permanent removal of malodours.
Leaves the treated rooms with a clean, fresh and natural smell.
An excellent and environmentally friendly alternative to ozone treatment.
First aid for soot and smoke odours after fire damage in large buildings such as warehouses, schools, shopping malls, factory halls, offices, etc.


After a fire in large areas as described above, the smell of smoke can be a huge challenge for employees and all other people who visit buildings with extensive odours. Here, the VaporShark, as one of the only products on the market, provides ECO-friendly first aid to immediately reduce/control odours, improve indoor climate and thus avoid odour complaints from employees, guests, visitors, etc.
A: In large areas, you can place one or more VaporSharks which will immediately reduce the smell. The VaporShark will quickly spread the well-known and effective odour neutralizing dry vapour from Neutrox Gamma oil, SOS oil (Smoke Odour Solution) or the natural citrus oils from our "Fresh & Clean Citrus Concept", Lemon or Summer Orange.
B: In very large rooms/halls, you can increase the effect of the VaporShark by placing its air outlet in front of the air intake on an air mover (see picture 2), which will then spread the dry vapour over larger areas. You can use several VaporSharks in large areas and thereby ensure that the entire affected area is treated by Vaportek’s odour neutralizing dry vapour to the satisfaction of everyone who works or visits the building.
C: Alternatively, you can also connect a VaporShark to the central ventilation system (see image 1) to treat all rooms in the building with active dry vapour from just one VaporShark. By running a 2" flex hose from the VaporShark’s air outlet directly into the ventilation duct, active dry vapour will spread via the ventilation system to all affected rooms and thus eliminate unpleasant odours.












GET THE MOST OUT OF VAPORTEK PRODUCTS AND GET HAPPY CUSTOMERS
The VaporShark is excellent to use right after the fire is out. Residents, neighbors etc. are frustrated by the strong smell of soot. The VaporShark will alone or combined with other Vaportek products such as Neutrox Gamma Bricks, SOS Bricks and ECOZ concentrates help to reduce the strong and unpleasant smell of smoke and soot, and complaints about odour nuisances are reduced or eliminated completely.






The Vaporshark is particularly suitable for the permanent removal of odour nuisances after a fire and can be used during the entire remediation process. The standard procedure is to wash all surfaces with alkaline detergent and use ECOZ liquid odour elimination concentrate in your rinse water. Then you can use a Vaporshark which will remove any residual odour after cleaning. We recommend that you use a membrane with SOS oil (Smoke Odour Solution) or with Neutrox Gamma oil in the Vaporshark. For lighter odour removal, our fresh Lemon and Summer Orange membranes from our Fresh & Clean Citrus Concept are very popular.






Use Vaportek as first aid for odours. Avoid odour complaints and get happy customers.

GET THE MOST OUT OF VAPORTEK PRODUCTS AND GET HAPPY CUSTOMERS
Place the VaporSharken in front of the air intake of an airmover and effectively spread the active dry vapour from the VaporShark to a larger area.





The Vaporshark can be used for odour treatment of contents and textiles. The tiny essential oil molecules from the active dry vapour will quickly penetrate materials and textiles. We recommend using Vaportek Lemon or SOS membranes for this purpose.


HARD-TO-REACH AREAS
It can be difficult to treat odours in hard-to-reach areas, but here the VaporShark can also help. By mounting a 2" flex hose on the VaporShark’s air outlet, active odour-neutralizing dry vapour can be directed into hard-to-reach areas, such as floor separations, crawl spaces, attics, under floors and all other types of cavities where dry vapour can be injected via flex hoses.












Leading car manufacturers worldwide use and recommend Vaportek technology for their global dealer network. Why? Because Vaportek is an environmentally friendly technology, it works every time and is easy to use. Cars that smell cannot be sold - Vaportek solves this problem in an environmentally friendly and efficient way.
In addition to car dealers, other industries and business areas also use Vaportek’s Restorator. Hotels, restaurants, real estate agents, property management companies, transport companies, cleaning companies, damage restoration companies, pest control companies, the industry and many other all over the world enjoy Vaportek’s versatile, ECO-friendly and highly effective products.


If you are an OEM (Original Equipment Manufacturer) and interested in finding out whether Vaportek’s technology can be incorporated into your products/product solutions, please contact us.
Vaportek cooperates with manufacturers of equipment and products for air purification, air refinement, aromatherapy, products for handling waste, waste water, etc.
Vaportek is happy to manufacture special solutions for your needs and purpose. Vaportek’s versatile product range means that we can certainly find a solution for your exact needs.
Implement a unique and sustainable solution in your machines, processes and equipment, etc. to remove or control odours. Take advantage of the power of nature, Vaportek’s extensive experience and versatile and effective product range. Together we will find the perfect solution.
We are interested in hearing about your thoughts and ideas. We are happy to offer a creative and sustainable solution. Contact us for a non-binding meeting!





NAC EUROPE PRESENTS THE NEW ODOUR REMEDIATION CONCEPT, WHERE YOU GET "THE BEST OF BOTH WORLDS"
NAC Europe was established in 2001 with Vaportek as one of the main products in our then modest product range. Since 2001, NAC Europe has expanded its product range considerably with technical equipment and chemicals, etc. from a number of recognized and innovative global manufacturers.
In 2024 we presented our new website with a number of new products, as well as several new concepts, including a completely new odour remediation concept which is based on THE BEST OF BOTH WORLDS
However, NAC Europe is known in the industry as the company that challenges its customers by launching new technologies that we believe offer new and more advantages in an industry that needs fast and efficient results.
Vaportek is based on natural plant extracts and works through special processes, where the natural and powerful essential oils react with odour molecules in a process called "Zwaardemaker Pairs". See pages 16-18.
Now NAC Europe is introducing a new concept where we combine Vaportek with new product technologies that work through oxidation and adsorption.
With the new concept, we give our customers the opportunity to combine different odour removal methods, with the aim of optimizing the odour remediation process in terms of speed, efficiency, sustainability and user-friendliness.

We hope our customers will welcome this new concept.
















Damage restoration companies worldwide have benefited from the Vaportek technology since the early 80s and are today among Vaportek’s core customers. Vaportek products are highly respected among professionals because Vaportek provides damage restoration companies with many options for controlling and eliminating odours in an environmentally and user-friendly manner. The ECOfriendly Vaportek products contribute to effective and permanent odour removal throughout the entire remediation pro-
cess and stand out through their versatility and quick effect – especially in the case of sudden odour problems. Vaportek is used for fire damage, water damage, sewage damage, odour from pests, unattended death cleanup, etc.
Vaportek can be used alone or combined with other odour remediation methods, e.g. NAC’s CLO2 (chlorine dioxide) based products or our H2O2 (hydrogen peroxide) based products, etc. Contact us for further information.
Vaportek plays a central role in NAC’s new odour remediation concept: "NAC’s ODOUR MANAGEMENT CONCEPT".
ANIMAL HOSPITALS, KENNELS & PETS
Odours from pets in private homes, in animal hospitals, kennels, etc. is a known problem. The Vaportek products are used to neutralize urine odour and all other odours on hard surfaces as well
as porous surfaces such as textiles etc. Bio-C, Neutrox Gamma Bricks and the Restorator are examples of Vaportek products that help to remove and reduce annoying odours originating from all kinds of pets.
The cleaning industry can effectively utilize Vaportek technology. In recent years, the trend within the cleaning industry has been to clean with products that are Swan-labelled and fragrancefree. Artificial fragrances only mask the bad smell and are therefore not a sustainable solution to odour problems in institutions such as schools, nursing homes, hospitals, the industry in general, etc.
However, the need to remove and control malodours is always relevant in many indoor environments, and here the versatile Vaportek products, which are based on 100% natural ingredients, can be of great help. The smell can come from several sources, such as urine, household waste, tobacco smell, vomit, sewage, mould, sweat etc. and with the wide Vaportek range we always find a solution together with our customers to effectively and sustainably control and remove bad odours.

Odours in apartments and houses originating from years of smoking, pets, urine, deaths, mould, etc. can be a big challenge to remove when new tenants and buyers take over the property.


Hospitals, care homes, housing communities, schools are often plagued by odours originating from urine (incontinence), faeces, vomit, sweat, tobacco smoke, etc.
In the late 70’s, the Vaportek technology was originally developed to remove mal-
With 20+ years of experience in the damage restoration industry, NAC Europe has the skills and products to effectively transform a smelly property into a 100% odour-free one! Result – no complaints on takeover, and faster sale of properties.
odours in cancer wards in American hospitals, and the success here created the foundation for Vaportek’s worldwide success. Today, Vaportek products are used in thousands of institutions worldwide, where odours are controlled in an effective and sustainable way.
The use of different types of fertilizer and other nutrient solutions, high humidity and bacterial growth, etc. can lead to odour nuisance in greenhouses in general. With the increase in cannabis production for medicinal purposes, odour problems have also arisen.
The cannabis plant produces terpenes which are responsible for the characteristic smell that the plant emits. Terpenes are strong-smelling hydrocarbons that are formed in the plant, with the purpose of protecting itself from herbivores or
by attracting "predators" that eat herbivores. The smell of cannabis can become a big problem for neighbors of cannabis producers.
Vaportek’s active dry vapour, consisting of many different plant extracts (essential) oils, has over a number of years proven to be very effective in eliminating the smell of the strong terpenes. Contact NAC Europe for further information. NAC Europe offers both Vaportek odour treatment products as well as advanced disinfectants for disinfecting irrigation water within professional plant production.







No hotel guests accept bad smells in hotel rooms. Odours in hotel rooms originating from tobacco smoke, vomit, sweat, food etc. makes the room impossible to rent out, and costs hotels a lot of money every year in lost income and reputation.
Leading hotels worldwide use Bio-C concentrate, Neutrox Gamma Bricks, Aroma
Bricks or the Restorator machine, etc. for super effective and complete odour removal within 30-60 min. or shorter, with guarantee.
If it concerns smells from food, garbage, smoke, vomit, urine in hotel rooms, hotel corridors, toilets, waste rooms, etc. there is always one or more Vaportek products that solve the task immediately.
The food industry, wastewater treatment plants, waste incineration, biogas plants, rendering plants, etc. have in common that they all have one or more production processes that cause malodours within the manufacturing facility.
It can be odours in production halls, from waste water, from grease separators, from raw material storage, in waste
rooms, etc., which spread to adjacent rooms and facilities, to the great inconvenience of employees, visitors, etc.
Vaportek products such as Bio-C, VaporShark, Neutrox Gamma Bricks, HeavyDuty Standalone cartridges, etc. is used worldwide for effective treatment and neutralization of odours, in many different industries.
The transport industry can have many challenges with odours in cars, trucks, containers, etc.
A lorry or container that has developed an odour problem, for example due to transport of smelly goods, cannot be used again until the smell is gone, as strong odours typically will give off the
smell to new goods and penetrate cardboard boxes and other materials. Furthermore, problems with odour are also a problem in many passenger cars due to cigarette smoke, dog transport, sweat and many other reasons. Vaportek has many different solutions that can eliminate odours within the transport industry.
Vaportek FACT
The sense of smell is linked directly to the area of the brain called the limbic system which controls memory, emotions and instinctive behaviour. If it smells clean and nice after having completed a damage restoration job – the customer perceives it as positive. It provides a positive image of your company and therefore significantly strengthens your competitiveness.

Vaportek FACT
The Vaportek method is not a masking of smell, but an odour neutralization based on the use of "VAN DER WAAL´s FORCE" and "ZWAARDEMAKER PAIRS".
See pages 16-18.


Vaportek products are SIMPLE TO USE
Vaportek products are PURE PLANT ENERGY
BASED ON THE FORCES OF NATURE
Vaportek products are ECONOMICAL TO USE
Vaportek products give you many OPTIONS